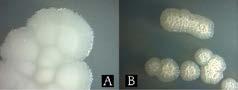

-
-

-

-
-












-
-

-

-
-











As industry experts, we fully understand the unique challenges you face in the aquafeed industry. That’s why we are committed to assist you throughout the entire journey, from concept to complete installation. Ready to reinvent your aquafeed operations?
As we were preparing to go to press in mid-February, I was travelling to San Antonio, Texas, to attend the 2024 Aquaculture America ’Setting the Table for US Aquaculture’ event which is likely to attract over 2000 delegates and attendees, including a umber from outside the USA and those attending from Latin America in particular.
 Roger Gilbert Publisher – International Aquafeed and Fish Farming Technology
Roger Gilbert Publisher – International Aquafeed and Fish Farming Technology
While you might at times think IAF focuses too frequently on events, this one in particular – along with all the others organised by the World Aquaculture Society - is one “must attend” event in my calendar each year. This WAS event has a range of conferences that will host 67 concurrent sessions with multiple presentations over its threedays here in downtown San Antonio.
There is certainly something that will satisfy the interests of everyone involved in the production of farmed fish and other food-based products, while not overlooking related issues around water quality and aquaria.
Over the next three years WAS will host 11 similar events throughout the world.
If you are at all involved is aquaculture, this is the event platform you should be attending, or planning to attend if you have not yet been invited to do so.
Of course, IAF and its break-away sister publication Fish Farming Technology will be distributing copies of their magazines and the industry’s annual directory at this week’s event and all these listed above.
That reminds me that we need to reiterate our plans to separate Fish Farming Technology from International Aquafeed, although for the time being we will publish both together. Each will have its own editorial profile and independent editorial management.
At some point in the future each may be published separately, but for now the goal is to produce both magazines together in their four languages which we publish each month.
You will find the Fish Farming Technology information in digital format on a combined website - which is shared between FFT and IAF - as well.
This development is in addition to the acquisition of the International Aquafeed Buyers Guide and Directory which now comes under the Perendale Publishers brand.
This Directory has developed a great reputation among those in the aquaculture industries and deals with not only the manufacture of fish feeds but also the ingredients and additives being used in their formulation. We are maintaining the established annual schedule of this Directory with the next edition to be produced in July this year for 2024-25.
I’m also pleased to note that we have now published four peerreviewed research contributions in our Aquafeed Journal along with their DOI numbers in place. They are freely available to download from our Journal page on the IAF website.
It may take a little time to achieve wider recognition of our Aquafeed Journal as we know referencing these papers will take
time and that is key to the success of the Journal in future. For now we are already making those published peer-reviewed papers widely available to our industries through our magazine, its website and its social media channels.
As I have mentioned before we want to ensure that the time between submission and publication (which will take into account the peer-reviewing process) is key to disseminating information in a time manner. After all our Perendale moto is: Being timely relevant and visible.
Finally, don’t overlook our great line-up of conferences coming up.
Particularly the two aqua-related one which take place on the same day preceding the VIV Animal Nutrition and Health expo in Bangkok, Thailand on March 11, 2024 (that’s the day before the opening of the event) in the BITEC Centre.
One is the full-day ‘Extrusion of Pet and Aqua Feeds’ conference and the other is the half-day ‘Aquatic - Future World Feed through Aquaculture’ conference .
See the information relating to these two event in our Events Section and be sure to register in advance of arrival.
Our feature sessions start with an article by our writer, Shannon Parsons, on women in aquaculture. With women’s days around the corner, I am sure this article will shed some light into the role of women in shaping the aquaculture industry.
We have multiple features in this magazine that will no-doubt catch the eye of our readers, such like a piece on Skretting, a Finnish insect ingredient producer, and how inset meal can be used for sustainable aquaculture.
Moving on from the health of our world, we then later on have a story that focuses on the health of our fish, with a feature from Vernon E Coyne and Sarah L Carrol from MariHealth Solutions.
Jumping ahead to the Fish Farming Technology section of our magazine, this edition begins with a story that focuses on aquaculture in Norway. As some of our readers may know we do in fact also release our magazine in Norwegian and with it being one of the largest sectors for fish farming it seemed only natural to do a feature story on the country and try to give our readers a brief overview of how the industry began, where it is today and where it possibly might end up in the future.
And finally ...
Congratulations to John Cooksey, the Executive Director of the World Aquaculture Society who was recognised and awarded on behalf of USA’s National Aquaculture Association for his outstanding contribution to the development and service to aquaculture, both in the USA and abroad. The award was made at the recent Aquaculture America 2024 held in San Antonio, Texas last month.
www.aquafeed.co.uk



Perendale Publishers Ltd
7 St George’s Terrace St James’ Square, Cheltenham, Glos, GL50 3PT, United Kingdom
Tel: +44 1242 267700
Publisher Roger Gilbert rogerg@perendale.co.uk
Managing Editor Joy (Jyothsna) Nelloolichalil joyn@perendale.co.uk
International Editors Dr Kangsen Mai (Chinese edition) mai@perendale.com
Prof Antonio Garza (Spanish edition) antoniog@perendale.com
Erik Hempel (Norwegian edition) erikh@perendale.com
Editorial Advisory Panel
- Dr Abdel- Fattah M. ElSayed - Dr Alessio Bonaldo - Dr Allen Wu - Prof Charles Bai - Dr Daniel Merrifield - Dr Domique Bureau - Dr Elisabete Matos - Dr Eric De-Muylder - Dr Noor Khan - Dr Pedro Encarnacao - Dr Philip Lyons
Editorial team
Prof Simon Davies sjdaquafeed@gmail.com
Shannon Parsons shannonp@perendale.co.uk
Niamh Cassidy niamhc@perendale.co.uk
International Marketing Team
Darren Parris
Tel: +44 7854 436407 darrenp@perendale.co.uk
Costa Skotidas +44 7826 545952 costas@perendale.co.uk
Latin America Marketing Team
Cristina María Roldán Otero
Tel: +44 1242 267700 cristinaperendale@gmail.com
Egyptian Marketing Team
Mohamed Baromh
Tel: +20 100 358 3839 mohamedb@perendale.com
India Marketing Team
Dr T.D. Babu +91 9884114721 tdbabu@aquafeed.org
Asia Marketing Team
Dante Feng
Tel: +886 0227930286 dantef@perendale.com
Nigeria Marketing Team
Nathan Nwosu
Tel: +234 8132 478092 nathann@perendale.com
Digital community manager
David Harvey
davidh@perendale.co.uk
Design Manager
James Taylor jamest@perendale.co.uk
Circulation & Events Manager
Tuti Tan
Tel: +44 1242 267706 tutit@perendale.co.uk
Development Manager
Antoine Tanguy antoinet@perendale.co.uk
Aquafeed Journal journal@perendale.co.uk
1

s we arrive in March, I am reminded of the saying ‘Beware the Ides of March’ as was told to Julius Caesar prior to his assassination by members of the senate. So, I will watch my back this month just in case anyone has such motives and avoid any senate, council meetings or workshops. The scientific world that I inhabit does certainly generate conflict, friction and especially with respect to research findings, interpretation of data and dissemination into journals and reports. The increasing interactive disciplines that underline aquaculture and nutrition relies on much cooperation and collaboration globally. I find that some 40 years since my PhD I am now more involved in complex multi-author research manuscripts that can have as many as 1218 authors and affiliations. The organisation of scientific papers takes much effort as many of our techniques in fish nutrition, feed technology, cross and even merge into fish immunology, histopathology, genetics and beyond. In this magazine, we receive excellent articles from industry that are very interesting to read and assimilate. There is much new information, and this reflects the advances being made in the commercial sector as well as in academia. In the production of scientific papers and articles it is now indeed a team effort and the days of the lone isolated professor working in the laboratory is more or less over as we need many specialist scientists working across the disciplines. I have had the pleasure of leading such groups and also participating in exciting projects that have forged alliances in Saudi Arabia, Egypt, and my affiliation as adjunct professor at the University of Galway in Ireland. I am also developing strong alliances in Indonesia working on shrimp and also in the southern hemisphere in Chile for studies to develop new protein feed ingredients for salmon. There is no doubt that international collaboration such as my association in Pakistan can lead to more in-depth studies and more stable platforms and can help to reduce the costs of advanced research investigations.
Lately, I have been researching the effects of functional yeast based ingredients for Pacific Whiteleg shrimp Litopenaeus vannamei with my Indonesian colleague Dr Romi Novriadi to assess effects on growth and feed utilisation performance and even more importantly capacity to supress pathogenic infection in controlled challenge studies. The ability to undertake such direct challenge tests with fish and shrimp is really very important but has been restricted to me in the past due to the very stringent UK regulations when I was at my previous academic base. The claims that various functional feed additives and supplements may impart immune-stimulation and positively prime the defensive systems of fish can often be shown at the enzymatic and gene expression levels to some degree, but the only definitive validation to prove their effectiveness in the mitigation of specific disease scenarios is by direct interaction (host/pathogen) methods and measurement of survival post infection. I am very fortunate that some of my work is now leading into that direction and coupled to the feeding trials. Of course, not many universities and even well-funded government institutions have the required bespoke resources and skills to mount fish and shrimp pathogen disease challenge studies. One will need to scale up the pathogen in question, infect the aquatic animal in isolation and maintain a very strict environmental containment and high biosecurity at all times.
In the news I see exciting prospects from the University of Stirling in Scotland for sea lice vaccines for Atlantic salmon that

could be the ‘holy grail’ to combat this major problem afflicting the industry. This would of course involve the aquafeed sector to develop optimised feed to carry the vaccine and ensure its efficacy in diet administration routes at various stages of production from freshwater to sea water phases.
Recently, I read about the innovative use of seaweeds as a functional supplementary ingredient for shrimp arising from Singapore and Indonesia. The products being promoted also include mineral ash from local volcanoes to enhance the trace element profile of shrimp feeds. Mineral ash is very high in vital elements for bone and tissue integrity. A small amount of ground mangrove leaves is also being incorporated into a mix of commercial feed. The current trials demonstrated a 15 percent improvement in survival and growth rates and a decrease in conventional feed that the farmer must purchase, which is the most significant cost and contribution to shrimp production.
Aquaculture is all about people and I am delighted to read about investment in the USA for indigenous Americans with tribal roots and pursuing rural enterprises. American Unagi (AU) is an eel producer selling a range of live as well as value-added eel (known locally as unagi) to clients including Michelin-star restaurants and fisheries markets throughout the United States. Rural Works (Investment group) funding will support American Unagi’s expansion in partnership with the Passamaquoddy tribe of Maine, to create jobs and encourage wealth distribution. This will help bridge the escalating demand for sustainably originated, traceable seafood, notably within the rapidly growing market for Japanese and Asian seafood in North America. I have worked before on eels and their nutrition is as expected, based on a high protein diet, and meeting a carnivorous mode of nutrition and feeding.
Also in the news, I am intrigued by the development of nano-bubble technology in Norway as a means to deliver oxygen more effectively to fish and this would be highly applicable to RAS containment which is now gaining momentum. Land based aquaculture is capturing the imagination, and we could raise fish in our cities, towns, and countryside. Gas exchange is vital and the bioenergetic oxygen demand for fish under intensive rearing conditions is critical to meeting faster growth and efficient feed conversion. The nano-bubble concept is really efficient for gaseous transfer and would ensure higher and more consistent dissolved oxygen in the system. This is very important for salmonid fish to efficiently utilise their metabolic dietary energy from protein, lipids, and carbohydrates.
With Spring in the air and increasing daylength in my part of then world, it is most welcome after a harsh winter. I hope to reach out again in April with more news and reports of the latest developments in this fish nutrition and health sector. Happy reading wherever you are.
Location:
Wesley Vale, Tasmania, Australia
Application:
Aqua Feed, dosing block

“In Tasmania, they had plans to convert a former cardboard factory into a fish feed factory. And so it happened.”
A funding boost from Invitalia, Italy’s Development Agency, is set to propel the realisation of Ittinsect’s pilot plant, which will produce 2500 tonnes of sustainable proteins when operating at full capacity.
This marks a key step toward the biotech company’s goal of scaling up to an industrial-scale production of proteins derived from 100 percent circular economy processes by 2025. This initiative highlights the importance of scaling up sustainable aquafeed for safeguarding our oceans.
Ittinsect will deploy EU€602,500 to build a section of its inaugural production facility. The facility will prove both the technical and economic advantages of Ittinsect’s
products at scale, laying the groundwork for the company’s first industrial plant. This scale-up will also bolster the recruitment of specialised personnel and the pursuit of new patents, solidifying Ittinsect’s position as the preeminent innovator in the market.
Ittinsect’s CEO, Alessandro Romano, underscored the significance of national support from Italy’s National Development Agency, stating, “We are honoured to secure this funding, building upon the trust already received from the Lazio Region during the project’s pre-seed phase. The backing from Invitalia confirms the regional interest has transcended into a national one. Our goal is now to extend the public support to an international level.”
Invitalia’s funding, facilitated through the Smart Start Italia initiative, totals EU€482,000, covering 80 percent of the EU€602,500 project expenses.





Visit



The Leiber Animal Nutrition develops and produces sustainable brewers‘ yeast products that helps to improve the health and productivity of fish and crustaceans in the long term.
Leiber® Beta-S
Highly purified ß-glucans
Immunity booster
Increased resilience
Improved vaccinations
Leiber® Beta-S Plus
The ß-glucan alternative
Synergistic blend of pure ß-glucans and MOS
We have been upcycling at world-market level since 1954 and keeping the environment and climate in mind.
CeFi® pro
Autolyzed brewers‘ yeast
Rich in nutrients and active ingredients
High bioavailability of the same Stimulates the metabolism
Promotes feed intake and performance
For us, sustainable behaviour is a vital component of our core business. After all, upcycling brewers’ yeast is at the heart of what Leiber has always been about – Give Yeast a Second Life.

Aquaculture Stewardship Council (ASC) is delighted to celebrate the first two pioneers to achieve certification against the requirements outlined in ASC’s Feed Standard: Mexicanbased feed producer Vimifos and the Chilean branch of global operation, Skretting. This marks a significant milestone in ASC’s mission to transform seafood farming towards more environmental and social responsibility.
Both Vimifos and Skretting undertook a rigorous audit process over several months for their sites. The conclusion of the audits has established that their processes and performances meet the Feed Standard’s robust environmental and social requirements. SCS was the independent certifier for Vimifos, whilst Control Union carried out the audit of Skretting Chile.
Vimifos was the first to achieve multi-site certification for three of its feed mills in Mexico that produce feed for shrimp, tilapia, trout and marine fish. Skretting has also achieved multi-site certification for two feed mills in Chile that produce feed for salmon.
Chris Ninnes, ASC CEO, said: “This is not only a milestone for Vimifos, Skretting and ASC, but pivotal for the whole industry to strengthen the credibility of fed seafood farming now and into the future. Our Feed Standard sets a higher benchmark for feed production. We applaud Vimifos and Skretting for their commitment to venturing into new territory with us – they are the trailblazers and their certification paves the way for the rest of the industry.
“There is no responsible seafood farming without responsible feed. Companies involved in its production face increased by reporting demands to assess the ‘upstream’ environmental and social impacts from feed-ingredient supply chains. By setting strict requirements for the sourcing of all major feed ingredients, ASC addresses environmental and social risks down to raw material level. Ensuring responsibility soured feed supports responsible seafood farming and thereby responsible sourcing of seafood products on shelves. With these first certifications, the journey towards more responsibility coming from greater transparency and traceability in feed production has gathered significant momentum.”
Skretting CEO Therese Log Bergjord commented: “We are extremely proud to be the first salmon feed company in the world to achieve ASC Feed Standard Certification. This is a highly demanding standard that moves in the right direction towards ensuring a positive impact across our supply chain, but we know that the journey doesn’t end here. We’re already implementing the learnings from Chile to accelerate the certification process across the rest of our operations and, with that, ensure that our customers can keep relying on Skretting to maintain their own certifications for fish and shrimp.”
With two further feed companies currently in audit for four sites in Thailand and Ecuador, the programme is gathering strength and increasing in global coverage. This progress shows that ASC is collaborating with a wider sphere of influence to drive positive change in the feed production industry.
As global demand for farmed seafood continues to grow, it is vital that the entire aquaculture supply chain transforms towards more environmental and social responsibility – the Feed Standards is a significant step in the right direction.

While marine ingredients have long been the benchmark for feed ingredients in aquafeeds, they are not without their limitations. For starters, there isn’t enough of them. However, when we start to look across the “spectrum” of ingredients that we might consider for using in aquafeeds, we quickly deduce that everything has a limitation of some sort. There is no such thing as the perfect ingredient.
It is in this perspective that a recent review was published that undertook a classic SWOT (strengths-weaknessesopportunities-threats) analysis of a range of ingredients, including marine, grain and terrestrial animal by-products and a range of novel ingredients as well (e.g., single-cell and insect). In the review it was noted that the technology readiness of these options varies across and within the different ingredient classes, but importantly it remains important to consider each of the ingredients in terms of the overall options out there.
By comparing the nutritional attributes of each of the various ingredient classes being examined, it became possible to apply an assessment framework based on understanding the critical knowledge required to be able to accommodate any ingredient in the formulation process. Notably, that assessment framework was based on the review “A feed is still only as good as its ingredients”, which proposed a series of steps based on; characterisation - palatability - digestibility - utilisation - accessory studies, and critically in that order. Once that framework was laid down, they progressed to comparing all the various ingredients. To do this they used a SWOT analysis, to make some consideration of what future potential may exist across the spectrum and what risks and opportunities each of the various ingredients might bring.
Perhaps the most critical thing noted was that all ingredients have strengths and weaknesses, and that there is no such thing as the perfect ingredient. However, by better appreciating the positive and negative attributes of each ingredient, it becomes possible to increase the adaptability in being able to respond to the various opportunities to their use in feeds. Another feature discussed was complementarity and the capacity of ingredients to work in synergy with other ingredients. As suggested, there may not be such a thing as the perfect ingredient, but maybe by harnessing the strengths of individual ingredients we have a better chance of making the perfect feed.


The National Aquaculture Association (NAA) awarded the McCraren award for Outstanding Contributions in Promoting the Growth of Aquaculture to Roger Barlow and the MacCaren award for Distinguished Lifetime Contributions to the Aquaculture Industry to Phil Mackey at the Aquaculture America event held in Texas this week. The NAA awards are given in honour of their first Executive Director Joe McCraren annually.
Roger Barlow has served as President of The Catfish Institute (TCI) for 20 years and added the role of Executive Vice President for Catfish Farmers of America 17 years ago. These organisations play vital roles in marketing, public affairs, lobbying and constituent relations for the U.S. Farm-Raised Catfish Industry, the largest aquaculture segment in North America.
His involvement in the industry includes working with marketing agencies to promote products, creating and maintaining marketing relationships, multiple yearly trips to Washington D.C. visiting congressional leaders, including the annual “Fish Fry on the Hill” and coordinating industry events such as the annual CFA convention.
Phil Mackey has been a trout farmer, ambassador, advocate, and pioneer in the aquaculture industry for
over 52 years. He is the principal owner and CEO of Mt. Lassen Trout Farm where he has been employed for the entirety of his career. Phil has many amazing contributions to the world of aquaculture but beyond that is the personal relationships he has formed; the folks he has helped along the way and fellowship he embodies is why he is so deserving of this prestigious award.
Phil has served as the president of the U.S. Trout Farmers Association (USTFA)twice and was the youngest ever elected to the position. He was instrumental in writing many of the initial position statements for the USTFA prior to the formation of the NAA. He chaired many technical sessions and travelled on behalf of the USTFA to industry meetings with USDA, APHIS and many other agencies wanting to regulate the aquaculture industry.
Phil was directly involved in the formation of the NAA and served on the initial Board of Directors. He has also served on the board for the California Aquaculture Association and continues to serve on the CA Aquaculture Disease Committee where he was the chairman for over ten years. He is also currently serving on the board for the CA Aquaculture Development Committee and has provided written and oral testimony as an aquaculture advocate for NPDES permits and similarly related issues in California. Phil also designed, built and ran a 104-acre catfish farm in CA. He has been directly involved in the design and construction of 16 cold and warm water fish farms while consulting on many more.




The Sustainable Aquaculture Innovation Centre (SAIC) has boosted the skillset of almost 500 individuals across the aquaculture sector since the launch of its skills programmes in 2014.
SAIC has equipped 200 academics with the skills to thrive in the seafood industry, including MSc scholarships, PhD funding, and paid work-placements. Its programmes have also upskilled a further 294 private sector workers and university researchers through a range of mentoring initiatives, leadership courses and digital skills training.
To commemorate the milestone, SAIC brought together industry leaders in skills development, a mix of early to mid-career professionals, and new entrants into the sector for an afternoon of networking and discussion at Dunblane Hydro. The ‘Nurturing Talent in Scottish Aquaculture’ event showcased the diverse initiatives in place to upskill the existing workforce and support the next generation of talent.
Jillian Couto-Phoenix, Head of Skills at SAIC, and Alison Gray, Founder and Director of Skillfluence, delivered the welcome address, highlighting the importance of skills and knowledge exchange in driving innovation with impact and safeguarding a sustainable future for the sector.
Up next was a leadership showcase, which involved a reflective Q&A session with a group of individuals who took part in SAIC’s nine-month leadership cohort. This was followed by a fireside chat with a panel of early to mid-career professionals who discussed their personal experiences and successes from the innovation centre’s various skills initiatives.
The event concluded with an open discussion on the power of mentoring programmes, shining a light on the Women in Scottish Aquaculture (WiSA) network and its impact on encouraging more women to enter and progress in the sector.
Heather Jones, CEO of SAIC, provided the closing remarks and encouraged the room to take advantage of the numerous collaborative working groups and partnerships that are helping to drive the whole sector forward.
Julian Couto-Hoenix said: “Over the last ten years, SAIC has existed primarily to connect industry needs with academic expertise via a portfolio of research and development. However, to facilitate the sharing and translation of this knowledge into new and improved practices, a connected pipeline of talented individuals is needed to turn these ideas into reality. Therefore, alongside our research and development, SAIC has been nurturing talent by creating cohorts of professionals from across organisations within the aquaculture sector with the purpose of innovating, leading and guiding careers.
“It was energising to hear from professionals from across a range of disciplines, telling us that our programmes have helped them to develop key skills which they have implemented at work and seen positive results. The keystone is consistent funding for skills and talent programmes – something. a sector with big plans to grow and scale needs to bump up the list, given the demonstrable positive effect.”



International Women’s Day, March 8, approaches and women around the world are praised for the hardships and accomplishments they’ve experienced and gained, yet still face numerous challenges. They are the backbone to aquaculture, making up at least 50 percent of the industry, and remain working behind the scenes mainly in developing and rural countries. Women are the unseen force in aquaculture and deserve the necessary tools to continue acting as such.
There has been an increase over the past decade of more women taking on larger roles in the industry but their recognition and the programs to encourage them into these positions have not grown alongside this increase. In the last few years especially, recognition for women in aquaculture has bounced almost like a yo-yo; programs, training and awards have been created to
encourage, empower and provide the tools and recognition women require and deserve in the industry.
The role of women in aquaculture benefits the industry in a variety of ways yet continue to face a multitude of barriers. These range from gender-based discrimination, to lack of resources and education/training, to having little to no time or chance to involve themselves in networking and marketing opportunities.
The reasoning behind these barriers can stem from either a lack of funding and/or assistance from the Government, cultural and societal norms, availability due to household work and childcare and more. Methods to encourage growth and change to allow women the appropriate education and resources they need within the aquaculture industry can be done through the help of the Government and stakeholders. They could provide financial aid and programs that assist women in the industry in various ways. There could also be changes made within the culture and society to reduce the discrimination women face and decrease the blockages against them that prevent them from gaining education.

There are many organisations, programs and charities that have been made over the years to help empower and provide women with the tools they need to thrive in aquaculture. Some are specific to their location while others remain global, this provides support both on a local and worldwide level. Some such organisations to look into are:
• Women in Fisheries – By and for the women involved in UK fisheries.
• African Women Fish Processors and Traders Network –Collaborative network joining female processors and traders throughout Africa.
• Women Economic Empowerment Bugiri (WEEB) –Alleviating poverty and offering women paid fishery labour in Bugiri, Uganda.
• Women in Ocean Food (Hatch Group) – Latin American focus on women entrepreneurs to develop successful ocean food companies.
• The Bloom (Seafood and Gender Equality/SAGE) - a networking community for women and genderqueer people in the seafood sector.
• Women in North America Aquaculture Summit 2024 – an online event to encourage the next generation of North American women in aquaculture.
Despite the hardships that women have faced in the industry, there are many that have played large roles to bolster aquaculture around the world. It would be a dishonour to not take a moment and look into the achievements these women have made, to apply what they have learnt or discovered to your own findings,
to utilise their resources and work with them. Mentioning some notable women from around the world within the industry and their achievements are:
• Nawa Consollata Muyangana, South Africa – Is the lead tilapia producer in Zambia with plans to increase production to up to 20,000 tonnes.
• Patricia Bianchi, UK – Improving and minimising the environmental impacts of seaweed production/farming working with the Marine Stewardship Council and Aquaculture Stewardship Council.
• Sam Macdonald, Canada– Creating and providing an immediate inspection solution as a method to allow farm operators and aquaculture specialists to have a deeper understanding of their submerged infrastructure and fish stocks.
• Ita Sualia, Indonesia – Worked with the UNIDO GQSP Indonesia team to assist in entering the fish processing units to the export market.
• Karlanea Brown, USA – Self-taught, she is the lead shrimp producer in Indiana for more than a decade.
• Fanny Giudicelli, France – CEO and Founder of Marine AKWA focused on developing research on marine ingredients dedicated to fish and shrimp farming.
Women are the backbone to aquaculture and despite the centuries of work they have put in, working as half of the industry and creating new innovations and solutions every day, they remain underappreciated. They deserve a voice and to have easier and more access to tools to help us improve the industry further.



 by Vernon E. Coyne & Sarah L. Carroll, MariHealth
by Vernon E. Coyne & Sarah L. Carroll, MariHealth
Like Sherlock Holmes with his magnifying glass, scrutinizing clues to solve complex cases, proteomics delves into the intricate network of cellular proteins which hold the secrets to metabolism, health, and resilience
Cape Town, South AfricaThe growing prominence of Blue Food in tackling food security worldwide has undoubtedly led to significant advancements in seafood farming practices and nutrition. However, intensification has led to the aquaculture industry facing challenges associated with high input costs, disease outbreaks and fish welfare management, with the latter being at the core of sustainable production of high-quality protein. Improving fish welfare requires a holistic approach to mitigating animal stress. This includes the use of novel feed ingredients

 Solutions,
Solutions,


that possess immunostimulant properties and the development of improved feed formulations, as well as optimised farming practices and improved vaccine development and application. As such, advancements in aquatic health are seeking to close the gap between veterinary medicine and aquaculture, with omics approaches paving the way for a more integrated and granular approach to fish health and welfare management (Figure 1).
“Omics” refers to high-throughput technologies that enable concurrent in-depth analysis of several biological molecules in a single sample. The application of omics technologies in aquaculture can support the identification and characterization of pathogens, and the identification of specific biomarkers of stress, disease or metabolic status of farmed aquatic animals that can be used to guide the development of novel feeds and therapeutics. Although proteomics is the most complex of the omics technologies, its application to fish health management, epidemiology, and disease research is becoming invaluable. Proteomics, the study of an organism’s entire proteome – the functional complement to the genome, focuses on characterizing
the structural, functional, and physiological role of all proteins in a cell, tissue, organ or organism at any given time and under specific environmental conditions. Like Sherlock Holmes with his magnifying glass, scrutinizing clues to solve complex cases, proteomics delves into the intricate network of cellular proteins which hold the secrets to metabolism, health, and resilience. Below, we explore how proteomics has the potential to ensure the sustainability of a fast-growing aquaculture industry, and how MariHealth Solutions is leveraging this potential, backed by 10+ years of scientific research at the University of Cape Town.
Proteomics today is a lot more advanced than it was in its formative years, with highly sensitive mass spectrometers offering researchers the ability to analyse more than 2000 proteins per sample! Coupled with improved bioinformatic software, proteomics is a formidable tool that can be used to address many of the challenges associated with health and welfare, nutrition, production, and quality of farmed aquatic animals (Figure 2).

Mitigating the impact of stress, both as a consequence of farming practices and climate change, on farmed fish and shellfish is crucial to improving animal welfare. Stress is characterized by a series of cellular responses that manifest in phenotypic changes in an animal, which can either improve survival or impair welfare. Conventional approaches to monitoring fish stress have largely relied on crude indicators, providing a limited understanding of the stress levels experienced by the animals. For example, cortisol is the most common indicator of the primary response to stress, but increasingly, studies indicate that cortisol is unreliable as a measure of long-term stress. Proteomics offers an unbiased and sensitive methodology for identifying potential biomarkers for monitoring stress. For example, in a study of Gilthead seabream exposed to three different stress conditions, proteins were assessed for their reliability as biomarkers of chronic stress compared to conventional hormonal and metabolic counterparts such as cortisol. The authors found high variability in the levels of cortisol, lactate and glucose in fish sampled from the same treatments. Furthermore, decreased levels of the hormones falsely suggested that the animals were adapting to the stressor, suggesting that these biomarkers were unreliable for assessing chronic stress. Conversely, proteomics provided more informed data regarding changes in the levels of proteins that function in critical immunological pathways, providing a solid foundation for an improved understanding of stress adaptation in farmed fish.
Fish health and welfare are closely interlinked, where poor animal welfare can be both a cause and a consequence of poor animal health. Thus, fish welfare is essential for sustainable aquaculture production. The application of proteomics as a means of assessing fish health has become an important complement to conventional approaches such as histopathology and disease symptomatology. A proteomic investigation of Streptococcus parauberis, a bacterial pathogen of Korean halibut (Paralichthys olivaceus) identified 82 differentially expressed proteins in kidney samples from healthy and infected fish with proteins that function in the immune response being the most up-regulated. In another study, the bacterial pathogen Yersinia ruckeri, the causative agent of enteric redmouth disease in salmonids, was shown to affect the expression of a wide range of kidney and spleen proteins in infected rainbow trout (Oncorhynchus mykiss), including several immune-related proteins which were significantly up-regulated
in the infected fish. The above-mentioned examples reflect the utility of proteomics in identifying and quantifying a multiplicity of proteins whose expression levels change in response to disease, rather than focusing on single or a few proteins that provide a limited assessment of fish health and consequently, welfare.
In recent years, the aquafeed sector has undergone a substantial shift in fish feed formulation to include sustainably sourced ingredients such as terrestrial plants and oils. These can affect the welfare of farmed fish due to feed components that limit effective digestion and intestinal function. As such, substantial research is focused on developing optimal feed formulations with novel additives for improved growth, without compromising fish welfare. The sensitivity and robustness of proteomics analysis makes it a critical tool for identifying metabolic targets that could modify protein networks and pathways for optimal fish growth. When fishmeal is replaced with plant proteins, it is important that the feed is supplemented with essential amino acids to circumvent poor feed consumption, low growth performance and consequently, compromised fish welfare. Thus, the proteome of Gilthead seabream was investigated to determine the effect of a plant-based diet supplemented with threonine, histidine and tryptophan. Proteomics analysis showed that tryptophan supplementation at the levels tested did not compromise growth performance and seemed to stimulate the immune system. The latter could prove advantageous to the welfare of the fish as it may increase the resistance of the fish to pathogenic infection.
Since proteomics has the potential to revolutionise the welfare of farmed fish through improved monitoring and assessment of farm practices and feed formulations, MariHealth Solutions was established to make the technology available to the aquaculture sector, fish feed producers and fish veterinarians. Already we have assisted clients to better understand issues they are facing such as slow growth (rainbow trout), failure to thrive in salt water (rainbow trout) and the effect of a particular feed additive on the immune system of rainbow trout. In summary, we provide critical decision support to the industry as we believe it is better to be proactive rather than reactive if the goal is to ensure the welfare of farmed fish and a sustainable aquaculture industry.
(References are available upon request)








If you can think it, we can pack it!








Skretting, a global leader in aquafeed solutions, and Volare, a Finnish insect ingredient producer, have agreed on a commercial collaboration to further enhance the sustainability and nutritional value of aquafeed products
Around 75 percent of the salmon farming carbon footprint arises from feed, and 95 percent of the feed footprint originates from raw materials, partnerships are essential for industry-wide change. One of the challenges is the cost-driven nature of the industry and the associated pressure on ingredients. The commitment of big companies and the entire value chain to novel ingredients before factories are built poses a challenge. Several aquafeed companies have been testing and even using insect meal commercially in recent years and insect-based products have proven to be well-suited for aquafeeds, while reducing the environmental impact of the industry.
Skretting, a global leader in aquafeed solutions, and Volare, a Finnish insect ingredient producer, have agreed on a commercial collaboration where Skretting has secured a substantial capacity in Volare’s forthcoming industrial factory in Finland for their Norwegian salmon feeds. Volare’s insect-based products offer an environmentally friendly solution to the evolving needs of aquafeeds, aligning with Skretting’s ambitious sustainability targets. By incorporating insect protein from Volare, Skretting aims to further enhance the sustainability and nutritional value of its aquafeed products, contributing to a more resilient seafood industry.
Volare’s innovative technology ensures low energy consumption, eliminates the need for fossil fuels, and produces zero wastewater, further enhancing the sustainability of the collaboration. Volare’s ingredient will reduce the CO2 emissions and reliance on wild fish in aquaculture.
“We are constantly looking for novel sustainable raw materials, and this is a welcomed addition to our current supply of insect meal. We need more volume, and this new Nordic supplier and their work to scale up the industrial production of ingredients is good for our industry. We are looking forward to the collaboration with Volare and their focus on sustainable and highquality products. This aligns perfectly with our values and goals”, says Erling Johansen, purchasing manager for special ingredients

at Skretting Norway.
The collaboration leverages the advantages of a Nordic partnership. Typically, the feed industry does not make advance commitments, but for important new sustainable ingredients companies are willing to break the pattern and commit to further improving the industry’s sustainability results.
“Skretting’s expertise and attitude have been impressive. Witnessing how well they understand their customers’ needs and how we can contribute to serving those needs has been inspiring. We look forward to a long-term partnership, creating a large-scale impact together”, says Jarna Hyvönen, Chief Commercial Officer at Volare.
Volare’s insect-based products offer environmental benefits compared to traditional aquafeed ingredients. In terms of protein, CO2 emissions are up to 8 times lower than soy-based alternatives, and there is reduced pressure on land and water usage. Importantly, there is no harm to oceans, in contrast to the potential negative impact of increasing fish meal use on wild fish stocks. In terms of Volare's oil product, the CO2 emissions are significantly lower than palm kernel oil and other plant-based alternatives, with also reduced land use. Volare’s inspiration to focus on insect-based solutions for addressing environmental challenges in aquafeed production stems from a desire to make the food chain more sustainable as quickly as possible and without requiring significant changes in consumer behavior. They see that moving human diets towards more aquaculture products is a way of making the diets more sustainable, and the growing industry will need to find sustainable and scalable solutions to ensure that it really is sustainable from several perspectives - not only emissions, but also from biodiversity on land and oceans point-of-view.
The feed industry is quite cost-driven and they saw that to make a difference in reality would require a solution that could reach price parity with existing ingredients used in aquafeeds. Insects
are indeed a scalable and cost-effective solution compared to high-cost and small-scale novel proteins. At the same time insects are a sustainable alternative from emission and biodiversity perspectives, while the production can also be located near the aquafeed production.
The genesis
Volare’s journey in developing insect-based products for aquafeeds began with extensive research at VTT technical research centre of Finland, driven inspiration to find a sustainable solution for the protein gap. The founders, Tuure Parviainen and Matti Tahtinen, came together while researching an ultra-efficient way to keep nutrients in the food chain – with the help of the black soldier fly. Volare’s varied research background is in all things circular economy, not limited to insect economy but also including energy technology, biogas and even emerging fields such as novel foods.
The concepts and technology developed in research now forms the backbone of Volare’s process — using food industry side streams. Volare’s team of engineers, agronomists, operators and researchers are building on decades of experience to create a truly circular future for the food industry. The original Volare plant is already in operation and serving customers in aquafeeds and pet food business. The foundres saw that they key elements driving both sustainability and cost-efficiency would be the use of side streams as raw materials and a proprietary dry processing method that reduces energy consumption by 30 percent, is non-fossil, all while producing zero wastewater.
They adopted a customer-centric approach from the outset and wanted to understand what were the product characteristics that are important for our customers and even their customers
nutritionally and technically.
“We have built the entire philosophy of the company on finding the most sustainable and cost-effective solutions while reaching high-quality products.
“We exclusively use side streams as raw materials and employ a proprietary dry processing methodology that uses about 30 percent less energy than traditional wet processing methods. This supports both our sustainability but also cost-efficiency. Our process is fully electric and non-fossil, yielding zero wastewater.
“We have conducted a Life Cycle Assessment (LCA) using the industry-standard PEFCR methodology to validate the environmental footprint of its products for the first industrialscale plant. One of our core values is learning, meaning that we constantly develop ourselves and our processes, finding better ways to do things every day.” Says Volare’s Co-founder and CEO Tuure Parviainen
Skretting and Volare envision this collaboration as the initial step in a long-term partnership. Volare already has an operational demonstration facility in Finland and will start delivering ingredients to Skretting in 2024. Volare will commence the construction of its first large-scale factory in 2024 and plans for multiple factories across Europe by the end of the decade.






Omnivorous fish species are known to be less requiring in terms of nutritional and palatability requirements and yet hydrolysate supplementation resulted in greatly improved production yields and incomes.
Several biological benefits are associated to protein hydrolysates, and they’ve been used in finfish larval and juvenile diets for several decades now, mostly due to their high palatability and digestibility.
Symrise Aqua Feed, which has been producing functional protein hydrolysates for more than 20 years, has recently promoted the long-term use of a new generation of liquid hydrolysates formulated to be used as Palatability Enhancers (PE, Extrapal range, references available upon request) in carnivorous fish species dietary formulations. These species are known to be requiring in terms of dietary compositions, with the need of palatable, raw materials, such as fish meal, but also in terms of welfare, being very sensitive to stressful events, which often result in feeding drops. In this context, the use of

PE is intuitive, and expected benefits are well perceived by both farmers and feed manufacturers.
In contrast, freshwater omnivorous fish species are not perceived as very requiring and considered as more robust. In these species, feed acceptance becomes an issue during very specific periods, such as wintering, and is therefore not perceived as a need. Challenges quoted by this industry are mostly related to feed costs and disease outbreaks.
Symrise Aqua Feed has developed a cost-effective solution to meet these needs by designing ActiTuna Oil. It has been formulated with the right balance of tuna oil and protein hydrolysate, to make its top coating application easier to feed manufacturers as a one step process. ActiTuna Oil has been designed to increase omnivorous fish feed palatability and digestibility with the reduction of feed production costs as a final purpose.
To evaluate ActiTuna Oil performance in omnivorous fish species, two feeding trials were implemented in tilapia and pabda, two fish species commonly farmed in Bangladesh. The study took place at Sylhet Agricultural University.
The same experimental design was implemented in both species. A basal diet was supplemented by top-coating 0.5, 1.0 or 2.0 percent of ActiTuna Oil and was benchmarked to the same basal diet alone. In tilapia, the basal diet consisted
 Figure 1a. and 1b. Tilapia and Pabda final mean weights (left bars, in g) and yield (right bars, in mT/ha) after 90 days of grow-out trial (p<0.001).
Figure 1a. and 1b. Tilapia and Pabda final mean weights (left bars, in g) and yield (right bars, in mT/ha) after 90 days of grow-out trial (p<0.001).

in a plant-based diet formulated to be as representative as possible of local commercial practices (31%CP and 6%CF, table 1.,) while in pabda, the basal diet consisted in a commercial diet (36%CP, 7%CF) locally available. Each dietary group consisted in 3 replicates i.e. a total of 12 cages of 3m² for each tested specie, at a stocking density of 100 fish per cage and an initial mean weight of 5.0 g for tilapia and 3.0 g for pabda. Fish were fed in excess twice a day at a fixed feeding rate (total distributed feed were 17g / tilapia individual and 20g / pabda individual) for 90 days. Water quality parameters remained within fish species requirements with following means: T°C:30.7±0.3, DO (ppm): 5.04±0.1, pH:6.95±0.07, ammonia (ppm): 0.06±0.04, nitrites (ppm): 0.08±0.04.
Both feeding trials were successful with very high survival and growth rates observed after 90 days. Thus, survival rates were at least 93% in both species while SGR were ranging from

3.46% to 4.15%/d for tilapia and from 1.93% to 2.33% for pabda. Dietary ActiTuna Oil graded supplementations resulted, in both fish species, in significant dose responses for fish mean weights (figures 1a. and 1b.). Maximum weight gains were observed for 2% supplementation with an increase of 86% for tilapia and 43% for pabda. Resulting production yields, as calculated in metric tons per hectare of rearing area, were increased by the same range of values (+97% and 52% for tilapia and pabda respectively). Since feed rations were fixed and remained the same thorough the whole trial duration, growth differences are mostly explained by a better feed utilization through two main patterns: enhanced feed palatability reducing feed waste and diet digestibility increasing diet assimilation, both being illustrated by FCR and PER values (figures 2a., 2b., 3a. and 3b.). Dose responses to dietary ActiTuna Oil graded supplementations were very high, with up to 49% and 34% FCR reductions in tilapia and



pabda respectively. These benefits can be further developed by 2 positive outcomes: 1. much higher PER values (Protein Efficiency Ratio, +92% and +44% for tilapia and pabda respectively) resulting in much lower nitrogen pollution in ponds and 2. much lower feed production costs, as defined by the invested feed costs in US$ per kilogram of produced biomass: -47% and – 33% for tilapia and pabda respectively.
Discussion & perspectives (ROI)
Functional hydrolysates from Symrise Aqua Feed Actipal range are designed to enhance feed palatability, feed efficiency and the overall health status of animals through specific peptide profiles. The synergic effect of water soluble free amino acids, short peptide chains and bioactive peptides brings out the optimal flavour of the feed, stimulating the taste buds and modulating metabolic pathways of the aquatic animals. This stimulation triggers a series of physiological and endocrinal responses, preparing the digestive system to properly digest the feed and modulate the microbiota in the gut.
These results show that there is still some room for feed cost optimization through better feed acceptance and assimilation, even in omnivorous fish species.
Figures 4a. and 4b. focus on the economic benefit of using ActiTuna Oil as a dietary performance enhancer. Bars show the expected sales revenues considering local tilapia and pabda farm gate prices (1.582 and 3.150 US$/kg of fish for tilapia and pabda, respectively). While feed costs remain the same, and by extrapolation other variable and fixed costs (seeds, electricity, wages…), revenues can be 96% (tilapia) or 51% (pabda) higher leaving a possible raw margin increased by 69% for pabda and 424% for tilapia productions, assuming other variable costs are negligeable compared to feed. Note that observed differences between the two species are explained by the fact that feeding trial started with bigger tilapia fish while this specie grows much faster than pabda.
Returns on investment (ROIs) were calculated doing the ratios


between revenue gains over feed investment costs. Logically, ROI increases followed the same pattern than raw margin ones. Maximum ROIs were observed for 2% ActiTuna Oil dietary supplementations: 144% and 460% for tilapia and pabda respectively.
Besides economic considerations, it is worth mentioning that a lower pond water pollution resulting from lower FCR will also contribute to better fish welfare, significantly reducing the risks of disease outbreaks and production losses.
The two feeding trials presented in this article typically illustrate the positive outcomes, which one may expect from the dietary application of a functional hydrolysate -ActiTuna Oil- by top coating (please see references). What is rather uncommon is the demonstration of such enhanced production figures in omnivorous fish species, generally considered less requiring in terms of dietary composition, nutrients, and palatability. Farm gate prices of these species are also usually lower than those of marine fish species, which leave less margin for sophisticated feed formula. However, estimated values of farm revenues, margins and feed ROIs demonstrated it is possible to generate much higher added values to omnivorous fish species feed formulas and farm productions. 2% dietary supplementation of ActiTuna Oil resulted in the maximum growth rates, yields, revenues, and ROIs. This combined solution can be easily applied by top coating at oil’s place.
We’ve detailed the positive outcomes expected by fish farmers (higher incomes, lower water pollution and disease risks) and mostly explained them by a higher feed acceptance (palatability) and assimilation (digestibility), which answer the industry needs of lower feed costs and disease risks, as introduced at the beginning of this article. Now, if considering feed manufacturers’ perspectives, top coating application of ActiTuna Oil will bring uniqueness and differentiation to standard formula, on which competition is tough, while giving formulators much more flexibility in terms of raw material choices, a great asset in these times of scarcity and cost volatilities!
DISCOVER
Our wide range of value-added services and understanding of production and market challenges worldwide, allows us to find the right technology and the most cost-effective solutions for your business in Livestock, Aquaculture/ Aquafeed and Pet industries






 Figure 4a. and 4b. Tilapia and Pabda feed related economics (costs and raw margin, out of sales, in US$/ha and ROI, in %) after 90 days of grow-out trial (p<0.01).
Figure 4a. and 4b. Tilapia and Pabda feed related economics (costs and raw margin, out of sales, in US$/ha and ROI, in %) after 90 days of grow-out trial (p<0.01).
 by Ivan Yu. Evdokimova,, Angelina V. Malkovaa, Alena N. Irkitovaa, Maksim V. Shirmanova, Altai state University and Dmitrii V. Dementyev, Arsal Limited Liability Company (LLC), Russia
by Ivan Yu. Evdokimova,, Angelina V. Malkovaa, Alena N. Irkitovaa, Maksim V. Shirmanova, Altai state University and Dmitrii V. Dementyev, Arsal Limited Liability Company (LLC), Russia
One of the main problems of the 21st century is the lack of food. In addition, aquaculture is an important source of nutrition for many people. Moreover, aquaculture today is one of the most promising sectors of agriculture. Breeding and rearing of aquatic animals is widespread in coastal countries, such as India, Thailand, Mexico, etc. [1, 2, 3]. The shrimp aquaculture industry can be distinguished as one of the most in demand. Its production exceeds millions of tons per year. But in the first place is still fish aquaculture
In the industrial breeding of crustaceans, farmers face problems such as infections and mass mortality due to them. Pathogens in the aquatic environment include representatives of the genus Vibrio Salmonella, Escherichia coli etc. Probiotics actively studied and used to improve the sanitary background of aquaculture enterprises.
A group of Indian scientists in a series of experiments carried out work on enriching Artemia with a Lactobacillus sporogenes supplement. Probiotic was used with different concentrations for further feeding to freshwater shrimp M. rosenbergii. According to their data, M. rosenbergii shrimp showed better survival, rapid growth and a greater content of protein, amino acids, carbohydrates, and lipids in the body after enrichment of mobile feed (Artemia crustaceans). They also proved that the concentration of L. sporogenes 6 × 108 CFU/g was optimal for the use of these microorganisms in foraging Spanish scientists conducted an experiment to analyze the effect of probiotic using as a means of combating potentially pathogenic members of the family Vibrionaceae. For this, they introduced a probiotic based on L. rhamnosus in the medium to A. metanauplii. As a result, they show a positive effect of L. rhamnosus on crustaceans. It was expressed in the level of
pathogens decrease by a whole order of magnitude compared to control.
Scientists from India conducted a similar study. They studied the effect of a probiotic supplement based on Saccharomyces boulardii on a pathogenic microorganism. Researchers found that yeast-enriched Artemia nauplii, after artificially infected by representatives of Vibrio, have improved resistance to infection. This proved the positive effect of S. boulardii microorganisms on Artemia.
Scientists from Iran carried out work to assess the impact of the Artemia enrichment with a Bacillus subtilis probiotic supplement on the growth, reproduction, microflora and resistance to Aeromonas hydrophila for ornamental fish Poecilia latipinna. They found that the enrichment of Artemia positively affects the parameters of the test group of fish. It also was found that there are no significant differences in the ontogenesis of enriched and unenriched Artemia groups.
A group of Indian scientists conducted research on the enrichment of nauplii A. parthenogenetica by various microorganisms: L. rhamnosus, B. coagulans. During the experiment, the intestine load and the retention time in the intestine of the Artemia nauplii of probiotic supplements were studied. As a result, scientists revealed that the nauplii of Artemia enriched with L. rhamnosus reached the filled state of the intestine after 39 ± 1.41 minutes, and the enriched nauplii of B. coagulans - after 39.5 ± 0.71 minutes. The load on the intestine and the retention time in the intestine varied in experimental groups.
From the above data, it can be see that well-studied microorganisms of the genera Lactobacillus and Bacillus are the most often appear in the composition of probiotic preparations. For the sustainable aquaculture development, it is necessary to increase the pool of microorganisms used as probiotics for hydrobionts. It is also necessary to expand the range of preparations based on a consortium of microbes, rather than monocultures.
The purpose of the work was to study the use effectiveness of a new probiotic based on the strains B. toyonensis B-13249 and B. pumilus B-13250 consortium in incubating Artemia franciscana cysts using mechanical counting and automatic calculation by dint of a convolutional neural network.
A consortium based on B. toyonensis B-13249 and B. pumilus B-13250 strains (Figure 1) from the collection [19, 20] was selected as the active component of the biopreparation for research
The following nutrients were use in the work:
L-medium (g/l): yeast extract – 5.0; peptone – 15.0; NaCl – 5.0; agar – 15.0; distilled water – 1.0 l. Vegetative nutrient medium (g/l): yeast extract – 5; peptone – 3; NaH2PO4 – 1; K2HPO4 – 4; MgSO4 – 0.25; MnSO4 – 0.03; NaCl – 1; CaCl2 – 1; FeSO4 –0.01; glucose – 15; H2O – up to 1 l. (pH 6.8-7.0). Fermentative nutrient medium (g/l): molasses – 25; corn extract - 12.5; yeast extract – 1; tripton – 0.5; MgSO4 – 0.25; MnSO4 – 0.03; CoCl2 – 1; saline runoff – 10 μl; H2O – 1 l. Cryoprotective medium (g/l): gelatin – 25, sucrose – 100 [21].
Production of an experimental probiotic lot
The development of an experimental-industrial lot of probiotic for testing also carried out based on the laboratory EC Prombiotech of Altai State University (Barnaul, Russia). The finished product includes a composition of B. toyonensis B-13249 and B. pumilus B-13250 strains, which were cultivated separately and mixed after drying.
To prepare the mother culture the strains inoculated by loop in 500 ml flasks with 150 ml of medium. Bacteria were cultured

Above - Figure 1: Morphology of used strains colonies on L-medium (x10): A - B. toyonensis, B-13249; B. pumilus B-13250
Below - Figure 2: Incubation cones with Artemia cysts

in “Innova 44” shaker-incubator at 37 °C about 24 hours at 250 rpm (eccentricity 5 cm). The number of bacilli, the check of the fermentation process and the finished preparation purity were carried out using spread plate method. Petri dishes were incubated in a “Binder BD 115” thermostat at 37 °C for 24 hours.




Deep cultivation of each strain carried out in bioreactors with a volume of 15 and 250 liters. To obtain more B. pumilus and B. toyonensis biomass, fermentation carried out in a 250 l bioreactor with a Fermentative culture medium. Having previously grown microbial cultures of bacilli to the stage of active division on a Vegetative nutrient medium in a bioreactor by 15 liters. Before loading the nutrient medium, bioreactor and individual air filter previously sterilized with sharp steam for 1 hour at 121-125 ° C and a pressure of 0.13-0.15 MPa.
After the fermenter was inoculated, the temperature of the culture liquid maintained at 37 ± 1 °C. At the beginning of the process, sterile air continuously supplied to the fermenter in an amount of 0.5 l/min per 1 l of medium and the pressure maintained at 0.02-0.03 MPa, stirring at 250 rpm. Sterile sampling carried out every 2 hours to observe the development of bacterial culture, morphological state and absence of extraneous microflora, as well as measurements of the optical density of the culture fluid (at 490 nm).
The target product (biomass) separated by centrifugation on the flow GTGQ-1251 Tubular Centrifuge at 15000 rpm. After concentration, the biomass was mixed with the Cryoprotective medium, frozen and sent to the chamber of the freeze-dryer “SP Scientific 25l Genesis SQ Super ES-55”. The drying time was about 40 hours, after which the dried concentrate tested for moisture content on a Shimadzu MOC63u humidity analyzer. The optimum moisture content of the finished concentrate is less than 5%.
The obtained concentrates mixed with each over and with a filler – maltodextrin until the final number of bacteria in the preparation (at least 1 × 1010 CFU/g). The ratio of B. toyonensis to B. pumilus was always 1:3, since the B. pumilus strain develops a higher abundance. Therefore, its predominance in the preparation is economically justified.
The study was carried out in laboratory of Arsal LLC in Yarovoye, Russia. The experiment used the A. franciscana cysts of two lots of two different lakes: Z29.04 (Lake Big Yarovoye) and C9 (Lake Kuchuk). Cysts incubated in cones (Figure 2) during 48 h at a constant bubbling air and standard conditions: the volume of incubatory solution – 1 l, salinity – 30 ‰, temperature – 25-30 °C, рН – 8.0-8.5, the oxidation-reduction potential (ORP) – 148-220 mV, illumination – 1500-2000 lux., quantity of the brought cysts – 2.0 g, the activator – 0.2 ml of 3% H2O2 solution.
The experiment consisted of four variants for each eggs lot (1 – control, 2, 3, 4 – experimental variants) in 24 repetitions. Incubation of both lots nauplii was carried out using probiotic doses (g): 0 (control), 0.05, 0.1, 0.2 respectively. The probiotic directly introduced into the cone with the incubation solution simultaneously with the start of the incubation process. After 48 hours of incubation, the number of crustaceans or nauplii (N), cysts (C) and embryos (U – umbrellas) counted in each cone. After that, the hatching rate (HR) calculated using the standard method and the biomass coefficient corresponding to the multiplicity of the increase in the total crude mass compared to the mass of the dry egg originally introduced.
Until now, industrial manufacturers of Artemia crustaceans carried out the counting process by visual method – using a binocular and microscope. It takes a large amount of time, measurement accuracy, due to fatigue and constant attention is not always correct. In addition, to save at least any data you have


Mean differences between the control and each of the experimental cones are significant at P<0.05
2:
Mean differences between the control and each of the experimental cones are significant at P<0.05
to use additional devices or gadgets.
To reduce statistical error, at least 8 times repetition is required. To reduce the time of counting, increase the accuracy and save data, in our work an Artemia robot counter with an algorithm based on a convolutional neural network (CNN) was used for the first time in the Russian Federation. The CNN used the algorithm YOLO (You Only Look Once).
A dataset of 1200 hand-labeled photomicrographs of brine shrimp samples was used to train the neural network (Figure 3). Each sample was 0.1 ml of water from an incubator with a random number of non-hatched cysts, embryos and hatched nauplii.
All objects were marked on each sample; their calculation is the task of the neural network. The total number of marked images (dataset) was divided into two unequal parts – a training sample (about 800 images), from which the neural network learns, and a test sample (400 images), on which the neural network checks itself. Figure 4 shows photos in the sizes and qualities on which the neural network trained.
The images enlarged from their original sizes. Photo resolutions: the number of pixels per unit area is sufficient for the operation of the neural network, since the natural dimensions
of objects in the visual visibility of the detector are commensurate with the samples specified for training the CNN.
Neural network training took place in the cloud service GoogleColab with connection to the Nvidia K80s, T4s, P4s and P100s graphics processors. Upon completion of training, the so-called neural network weights obtained – settings of parameters by which the neural network most accurately determines the objects sought in the image. Subsequently, weights were loaded from the cloud service for the possibility of applying them already offline.
The mechanical part of the robot was also developed and built in the Russian Federation, and the entire complex of automatic counting of nauplii called «Artemetr-1» (Figure 5).
Effect of probiotic on incubation rates of A. franciscana cysts
Classical (mechanical) counting (45 seconds/sample)
The results of the study on the lot of cysts Z29.04 presented in Table 1, and on the lot of cysts C9 – in Table 2. Moreover, with
both lots the best results on biomass yield obtained by adding 0.1 g of probiotic per 2 g of dry cysts. The hatching percentage when adding a probiotic to a Z29.04

 Table 3: Comparison of classical (mechanical) and automatic counting of Artemia nauplii
Table 3: Comparison of classical (mechanical) and automatic counting of Artemia nauplii
lot changes not so significantly compared to the control but improves by 1.4% maximum. CV from 3 to 5% indicates a slight spread of values and allows us to talk about the reliability of the result.
When adding a biopreparation to a C9 lot, an increase in HR of about 10% is noted. The coefficient of variation when working with the second experimental lot was significantly higher (6.411.8%), but remained at an acceptable level to speak of the reliability of the result. In this case, the lowest variation observed in the experimental group with the addition of 0.1 g of probiotic.
The biomass yield shows what mass of Artemia crustaceans turned out after incubation. The graph shows the results of the correlation between the applied dose of the probiotic and the biomass yield of Artemia franciscana from two independent batches taken from two different lakes (Fig. 6).
Various samples of A. franciscana cysts (C9 and Z29.04) have different hatching percentage and biomass yield in control cones. However, in both batches, there was a decrease in these indicators with the addition of 0.2 g of probiotic compared to the best result in cone 3 (with added 0,1 g of probiotic). With sample Z29.04 excessive dosage of the biological product contributed to significant indicators decrease to a level below the control values. The effect of the probiotic is most pronounced at initially low rates of hatching percentage and biomass yield, as in the case of the C9 lot.
The biomass coefficient shows how many times the mass of brine shrimp increases after incubation. The tables also present the results of the correlation between the applied dose of probiotic and the biomass coefficient of the studied lots of Artemia.
Validation of counting by convolutional neural network
To verify the validity of the results of automatic counting, the entire lot of 192 images additionally was checked by the classical (mechanical) method (Table 3).
According to the results of the inspection, no reliable differences between the counting methods were found. The entire set of obtained images (example – Figure 7) was saved, and it can be used for further research.
Shrimps are demanding on food mobility during feeding in the early stages of development. In this regard, the technology of feeding shrimp prelarvae with live, freshly hatched brine shrimp nauplii is widely used in aquaculture. The incubation solution for A. franciscana is a very favorable environment for the development of any, including unfavorable, microflora that affects the quality of the final product. The number of pathogenic bacteria in Artemia crustaceans increases exponentially during their hatching and nutrient enrichment processes. For the same reason, brine shrimp producers are interested in adding probiotic and prebiotic preparations to their product to transfer them to shrimp prelarvae and reduce the possible development of pathogens.
A large number of works in recent years have been devoted to the enrichment of Artemia with probiotic microorganisms for further feeding by crustaceans of other aquaculture objects. Therefore, this area of research is quite relevant. Since enrichment with beneficial non-pathogenic bacteria has a positive effect on cultivated species of various aquaculture objects by improving the intestinal microflora, eliminating pathogens and increasing nutritional value [32]. In addition, a number of recent scientific works aimed at fortifying the brine shrimp themselves to combat Vibrio bacteria as well as to generally increase the impact on the intestinal flora, the immune system and increasing resistance to many other pathogenic bacteria .



It known that the Artemia nauplii massively begin to hatch from cysts after 20 hours of incubation and after 6-8 hours after birth they begin actively feed. Therefore, during 48 hours of incubation, Artemia cysts not only inseminate the surface of the nauplii, but also populate their gastrointestinal tract with probiotic bacilli. The study revealed that with both lots of Artemia cysts the probiotic adding give a good effect. It is expressed as an increase in biomass compared to the control. In addition, a consortium of B. toyonensis B-13249 and B. pumilus B-13250 strains in the course of its vital activity probably favorably change the Artemia environmental conditions. This manifested in an increase of A. franciscana cysts hatching percentage in the trial compared to control. This may be due to the antagonistic properties of the used bacilli to pathogens. In our previous studies, we have found that B. toyonensis B-13249 and B. pumilus B-13250 had a pronounced antimicrobial effect on E. coli, Staphylococcus aureus, S. atyphimurium, Shigella sonnei, Pseudomonas aeruginosa.
In the first experimental group Z29.04 (samples of cysts from Lake Big Yarovoye) a noticeably higher percentage of hatching is observed. It is the norm of this Artemia lot and is not associated
Figure 7: Test images Figure 6: Probiotic concentration and biomass yield correlation
In aquaculture, fish and shrimp are constantly exposed to pathogen pressures, environmental fluctuations and other production stressors, negatively impacting survival and productivity.
At dsm-firmenich, we offer solutions to protect aquatic animals, reducing the risk of health and welfare challenges throughout the production cycle.
with the use or non-use of probiotic. The minimum spread of the Kuchuk lot (C9) indicators observed precisely in the experimental group with the addition of 0.1 g of probiotic. This may indirectly indicate a stabilizing effect of the probiotic on the hatching. Distinction in the hatching percentage in different samples of Artemia cysts (Z29.04 and C9) are due to the fact that they were obtained from divers salt lakes. Hence, they can characterize by various properties, because they evolved in different ecosystems.
Shrimp are demanding on the mobility of the feed during feeding in the early stages of development. In this regard, the technology of feeding shrimp prelarvae with live, newly hatched brine shrimp nauplii is widely used in aquaculture. The A. franciscana incubation solution is a very favorable environment for the any (including unfavorable) microflora development. Therefore, this can affect the quality of the final product. For this reason, the Artemia manufacturers are interested in probiotic and prebiotic adding to their products to reduce the possible pathogens development and transfer it to shrimp prelarvae.
The advantages of the developed Artemia robot counter with an algorithm based on a CNN repeatedly cover various complexities. These include the use of several devices at the same time, reducing the processing time of the received data, the ability to save data for future use, and reducing the time the operator is present.
The main difference between the YOLO algorithm and other neural network algorithms used to detect objects is instant detection of objects in real time. The principle of YOLO operation implies the introduction of a full-size image, which completely passes through the convolutional neural network once. In other algorithms, this process occurs many times.
At the time of the start of work, one of the most productive
neural networks for determining objects was the fourth version of this neural network – YOLOv4 (developed in 2020). Testing several neural networks from the MS COCO test sample (2017) of 127287 images showed the maximum performance of exactly YOLOv4. The YOLOv4 algorithm works 2 times faster than one of the most accurate and perfect EfficientDet. Compared to the older version, YOLOv3, the AP indicator (Average Precision) is improved by 10%, and the performance (FPS) is increased by 12% [36]. This led to its use as a platform for creating the “Artemeter-1” robot for the organisms counting.
The lack of reliable differences between mechanical and automatic counts confirms the high accuracy of the developed robotic counter. Its mass use will optimize the counting of nauplii, cysts and Artemia embryos during scientific research.
Thus, a new probiotic preparation based on B. toyonensis B-13249 and B. pumilus B-13250 strains has a positive effect on the hatching cysts percentage and the biomass yield of A. franciscana. The recommended dose is 0.1 g of biopreparation per 2 g of cysts. The increase in the hatching percentage when the probiotic added at a given concentration to the Z29.04 lot was 1.4% and when the biopreparation added to the C9 lot –10%. The biomass yield in the control cones for lots Z29.04 and C9 was 5.30 ± 0.60 g and 4.60 ± 0.50 g, respectively. When a probiotic added to these lots at a concentration of 0.1 g, the biomass yield was 7.40 ± 0.69 g and 6.80 ± 0.43 g, respectively.
A new robotic system for counting nauplii using machinelearning technologies has been successfully tested for the first time. “Artemetr-1” significantly reduces the processing time of samples (15 times per sample), the amount of labor and allows saving data for future use.




Petfood & Aquafeed Extrusion Conference (PAEC), held at VICTAM Health and Nutrition Asia 2024, will be on March 11, 2024. With a focus on the extrusion of feeds and the related equipment used, the one-day conference will feature a variety of speakers covering all the key-areas of the industry to give the latest extrusion information. Co-organised between Perendale Publishers Ltd and VIV Worldwide, PAEC will be held at BITEC, room 223 at 10:00am.
BITEC, Bangkok, Thailand
Part of Health and Nutrition Asia




09:30-10:00 Registration
10:00-10:15 Roger Gilbert - International Aquafeed magazine
Welcome
10:15-10:45
Dr Mian Riaz - Texas A&M University
Challenges adding fresh meat in pet food
10:45 - 11:00 Curtis Strahm - Wenger
Extrusion Flexibility: Producing Pet Food and Aquatic Feed on One System
11:00 - 11:20
Hadrien Delemazure - Clextral
Making Floating and Sinking feed using twin screw technology
11:20 - 11:35
11:35 - 12:00
Dana Nelson - Extru-tech Single Screw Extrusion of Premium Aquafeed
Dr. Sohail Nazari - Andritz
Step into the Future of Drying; Save up to 30% energy, reduce moisture, variability, and boost efficiency
12:00-13:00 LUNCH
13:00-13:30 Phil Erickson - Reynolds Engineering
Why Particle Size Matters in Aquaculture Feeds
13:30-14:00
Danny Chang - CPM IDAH Asia
Trends in drying and cooling shrimp feeds
14:00-14:30
Dr. Enzhi Michael Cheng - Famsun
Aqua Feed Production, Focusing on Precision and sustainability
14:30-14:45 Dr. Jay Bernard - Kemin Moisture, Oxidation and microbial growth control in Extruded Aquafeeds
14:45 - 15:00
15:00-15:15
Marco Prati - PLP Systems
Continuous atmospheric coating for feed
Khun Tanakorn Lothaka - USSEC Effects of Different Soybean Meal Inclusion Levels on Growth Performance of Pacific White Shrimp: Insights from a Commercial Demonstration
15:15-15:30 Q&A session
15:30 Closing
Organised by
Combining high throughput with outstanding accuracy, the ALFRA FCDxy features a unique dosing slide, which ensures that dosing and weighing is no longer a factory bottleneck. Uniquely, it eliminates labour-intensive and error-prone hand dosing –and the alternative of a separate machine for small amounts – by handling from 50 gram right up to 100 kg in a single machine.
Design features like an in-built dust extractor help ensure a clean workplace with minimum or even zero cross contamination. Cleaning, inspection and maintenance are all simple, and running costs are low.
The embedded ALFRA dose&weigh software uses historical data to start the coarse dosing and then adjusts the fine product flow profile dynamically, achieving up to 20% more throughput – even for materials with varying flow characteristics. The improved accuracy saves raw materials, while batch times are shorter and more predictable.

IDAH weighing and dosing systems are for precise weighing of bulk solids and monitor incoming raw ingredients, ensuring precise recipe formulation with bulk materials. Accurate and reliable system for handling powder and granular material to allow precise weighing. Can be used for material dosing of materials from bins. Controlled with auto batching software.
This weighing scale is designed for a wide variety of applications in weighing bulk solids, powdered, and granule materials. This weighing scale can be connected to the material batching system and automatically operated based on the formula in food, pet food, aqua feed, and animal feed industry.
Features and Benefits:
High-end load cell reduces maintenance cost
Gravimetric batch dosing system to fit different processing requirements
Round shape
hopper design for ranging 100~500 kg
Square shape hopper design for handling over 500 kg
Closed design hopper for lowdust operation idah.com

Extru-Tech horizontal dryers are the leading industry tool for the production of a diverse range of food and feed products, including pet and aquatic foods and foods for human consumption. Extru-Tech has taken dryer technology to the next level with the new Advanced Feature Dryer, which features improved performance and new sanitary dryer features.
The Advanced Feature Dryer is renowned for its balanced Air Circulation System. The addition of variable frequency direct drive fans provides uniform airflow across the entire width of the beds minimizing moisture deviation and providing flexibility to maintain even efficient drying regardless of product size, shape and density. The result is a finished product with less than 1/2 percentage point variation in moisture. Our new, redesigned chute is complete with span and speed controls for “in-process” adjustments, providing accurate product spread for even bed depth. www.extru-techinc.com


Something powerful happens when shared expertise, care and nutritional performance come together. Unrivaled solutions designed to advance your business forward. That is the transformational power of partnership.
#PowerOfZinpro





PAQ-Gro™ is a unique blend of natural ingredients especially formulated for aquaculture
An innovative product that supports health and productivity in aquaculture
Enhances growth performance and survival rate during the production: from the hatchery to the grow-out phases.
Effective in varied growth conditions including freshwater, saltwater and a wide range of water temperatures and environmental conditions.
Contact your local Phibro Aqua specialist for more information Or visit us at phibro-aqua.com

Technology is a wonderful thing. And it is a dangerous thing. It helps us improve our performance; it takes over routine tasks and is able to improve them; it helps us make more money. But it can also be a threat to mankind and it can be used for malicious or criminal purposes.
The global technological development has taken giant leaps in recent years, especially in 2023. And 2024 looks to promise even more dramatic developments on the technological front. This year, 2024, has been proclaimed by some as ‘the year of artificial intelligence’.
Artificial intelligence is already in use in a number of fields. In medicine and medical research, in information gathering, in analysis and decision making, in military operations, and even in fisheries and aquaculture.Top of Form
Artificial intelligence holds significant potential for revolutionizing fisheries and aquaculture industries by improving productivity, sustainability and efficiency.
Artificial intelligence technologies are used to monitor and manage fish populations and aquatic environments. Remote sensing, underwater cameras, and drones equipped with artificial intelligence algorithms enable real-time monitoring of fish stocks, water quality, and environmental conditions.
Artificial intelligence-driven solutions are used in aquaculture operations to optimize production processes, enhance yields, and reduce costs. Artificial intelligence algorithms analyse data on water quality, temperature, feeding patterns, and fish health to optimize feeding regimes, monitor water conditions, and prevent disease outbreaks. Predictive analytics help aquaculture farmers anticipate environmental changes and adapt farming practices accordingly.
Artificial intelligence technologies facilitate early detection and management of diseases in fish populations. Machine learning algorithms analyse biological and environmental data to identify disease outbreaks, predict disease spread, and recommend appropriate interventions. Artificial intelligence-powered diagnostic tools enable rapid and accurate identification of fish diseases, helping aquaculture farmers implement timely treatment measures and minimize economic losses.
Artificial intelligence enhances supply chain management in the fisheries and aquaculture industries by optimizing logistics, tracking product quality, and ensuring traceability and compliance with regulations. Artificial intelligence-driven systems enable real-time monitoring of fish movements, processing operations, and distribution channels, improving transparency and accountability throughout the supply chain.
In summary, artificial intelligence has the potential to transform fisheries and aquaculture industries by enhancing sustainability, improving resource management, and optimizing production processes.
However, it is essential to address ethical, societal, and regulatory considerations to ensure that artificial intelligence

technologies are developed and deployed responsibly for the benefit of society.
As anybody who is active on the net and using social media will know, cybercriminals have always been early adopters of the latest technology. Cybercriminals are using the latest technology to rob us online and lure us to give away vital information. Artificial intelligence is a powerful tool for cybercriminals and helps them become ever more efficient.
The relationship between cybercrime and artificial intelligence is multifaceted, with artificial intelligence presenting both opportunities and challenges for combating cyber threats. As artificial intelligence continues to advance, it is essential for organizations to stay abreast of the latest developments in cybersecurity to protect against evolving cyber threats.
The need for regulations
Artificial intelligence is today largely non-regulated. There are very few regulations relating to its use. With the many opportunities for misuse or criminal exploitation of the technology that it offers, regulations are needed.
Many nations are now looking into the field of regulations for artificial intelligence. According to the Artificial Intelligence Index at Stanford, which undertook a survey of 127 countries in 2021, as many as 37 laws on artificial intelligence were passed in 2022. Some 30 countries adopted dedicated national strategies for artificial intelligence between 2016 and 2020.
So it is starting to happen. But laws and regulations will probably not play an important role anyway, because just like the decisions of the International Court of Justice, nobody will pay attention to them because they are so difficult to enforce. Thus, cybercrime will continue to grow.
No matter whether we like it or not, artificial intelligence has come to stay. Some people, - most probably charlatans and criminals –, will find it useful in their efforts to cheat and steal, and other, slightly less demoralised people will recognize in it the opportunity to make more money.
So I am not enthusiastic about the spreading of artificial intelligence, in spite of its many positive aspects.


BioMar’s Aquaculture Technology Centre at Hirtshals Denmark opened a new wing dedicated to research and development in the hatchery segment. The Larviva Hatchery Hub trial facility was officially opened by BioMar’s CEO Carlos Diaz.
“We have a solid and fast-growing share in the hatchery segment, but we still see untapped potential as the segment continues to evolve,” noted Carlos Diaz at the opening.
In recent years the hatchery sector has seen consolidation with larger units and standardisation of protocols, as well as the introduction of new species with unique feeding behaviour.
“This facility is a dream come true for our Global Hatchery Team. Our goal is to ease production, reduce costs and provide stronger larvae,” said Global Hatchery

Product Manager, Joanna Amaral. “We have successfully reduced the need for rotifers and Artemia with early co-feeding and this new Larviva Hatchery Hub will enable us to continue to develop both diets and feeding protocols,” stated Joana Amaral.
High performance hatchery feeds are essential for creating strong and healthy fish and shrimp early in life as this leads to better survival rates and a more robust animal.
“The new facility is very advanced and versatile. It enables us to do trials with a very high degree of control over all production parameters. We can simulate conditions that our customers experience in different hatcheries around the world and do trials with both marine and freshwater larvae,” explained Simon Wadsworth Global R&D Director of BioMar Group.
BioMar’s Larviva hatchery feeds were first introduced in 2008 and are sold worldwide to both fish and shrimp species.
Bioriginal Food & Science Corp, a wholly owned subsidiary of Cooke Inc, has acquired POS Biosciences Corp of Saskatoon, from Canopy Growth Corp.
Proteins, Oils and Starches (POS), formerly known as KeyLeaf Life Sciences, will operate independently, guided by Jim Shields, the new Managing Director. Bioriginal will become POS’s largest vendor and customer, gaining access to POS’s state-of-the-art oil processing, concentration and molecular distillation facility designed to create value added oils and proteins. POS will also provide research and development services to Bioriginal using its 11 laboratories and six pilot plant processing areas.

nutrition industries.”
“We are grateful for the opportunity to acquire POS,” says Shannon Sears, President and CEO of Bioriginal. “POS’s world-leading processing technology combined with its team of scientists in new product development will play a key role in driving innovation for the human and pet
This is the fifth acquisition for Bioriginal in the past 12 months having purchased Softgel Co of Colorado, The Factory of The Netherlands, Kroppenstedter Ölmühle of Germany and Cana Corp of Japan. As a result of this transaction the Bioriginal group has eight manufacturing facilities on two continents supported by regional offices in Anahiem, California, Den Bommel, Netherlands and Yokohama, Japan, as well as 18 warehouses across the globe.


Temperature Adapted Feeds TM


Temperature Adapted Feeds TM
Temperature Adapted Feeds TM
The Spring Edition feed contains high doses of vitamin C to support and strengthen the fish during the challenging transition period - at no extra cost!
Vitamin C supports the formation of red blood cells and improves oxygen uptake
Vitamin C supports skin repair and wound healing
Temperature Adapted Feeds TM
Vitamin C improves stress resistance
Available for trout, carp, sea bream and sea bass.
Temperature Adapted Feeds TM
Topian, the NEOM Food Company working to futureproof food systems, marked the first day of the Saudi International Marine Exhibition & Conferences (SIMEC) with three strategic partnership agreements, aimed at strengthening Saudi Arabia’s position as a global leader in sustainable aquaculture.
Topian signed a key agreement with The National Livestock and Fisheries Development Program (NLFDP), focused on research and technological development, sustainable aquaculture practices in the Red Sea, and establishing a national seafood market.
As part of its commitment to envision a future marked by sustainability and innovation, Topian signed a Memorandum of Understanding (MoU) with Pure Salmon, a global leader based in Abu Dhabi, specialising in land-based aquaculture facilities featuring Recirculating Aquaculture Systems (RAS) technology, to establish a facility at NEOM that will cover the full value chain of salmon production. The facility, which will be the first of its kind in the region, will address the high demand for salmon in the Kingdom and neighbouring countries by delivering local products market by freshness, quality and taste.
Topian also signed an agreement with the National Aquaculture Group (NAQUA), aiming to contribute to the development of the local aquaculture sector, and to further commercialise NAQUA’s seafood products across the Saudi market.
Dr Ali Al-Shaikhi, CEO of the National Livestock and Fisheries Development Program and Director General of Fisheries at the Ministry of Environment, Water and Agriculture, stated that this agreement focuses on advancing the livestock and fisheries sector in four crucial areas.
“These encompass research, technological development and innovation to foster the growth of a sustainable aquaculture sector. The agreement specifically aims to develop collaborative procedures, establishing best practices and standards suited to the unique aquaculture ecosystem of the Red Sea. Additionally, the two entities will work together to create a scientific regulatory framework for licensing and monitoring activities. Furthermore, the agreement seeks to enhance the local seafood market, boosting the consumption rates of locally produced items, and implementing innovative genetic techniques to improve camel breeding practices” says Dr Ali Al-Shaikhi.
Stephane Farouze, Chairman and Founder of Pure Salmon, said: “We are thrilled to announce Pure Salmon’s strategic collaboration with Topian, the NEOM Food Company, to reshape the future of the aquaculture industry. This partnership underscores our shared commitment to innovation, sustainability and food security – a commitment that resonates with the Saudi Vision 2030. We look forward to working with NEOM to drive positive change and deliver high-quality protein solutions in the Kingdom and beyond.”
Diego Illingworth, Chief Executive Officer of the

National Aquaculture Group (NAQUA), said: “We are very pleased with the Memorandum of Understanding between Topian and NAQUA. This MoU represents a collaborative effort to explore new opportunities in aquaculture. Through this partnership, we aim to enhance our production methods and business strategies, focusing on efficiency and sustainability. The synergy between our companies is expected to lead to beneficial outcomes in terms of innovation and market reach. We are optimistic about the potential of this collaboration to contribute positively to the aquaculture sector in KSA and we look forward to the results of our combined efforts.”
Topian aims to drive sustainable aquaculture in the Kingdom by leveraging more robust and advanced technologies. A robust and dynamic aquaculture sector will support the enhancement of food security and selfsufficiency through sustainable production of fresh and healthy seafood within Saudi Arabia and beyond.
Topian recently joined the Saudi Agrifood Tech Alliance, spearheaded by the Ministry of Environment, Water and Agriculture. The Alliance is a national initiative that aims to unify and mobilise key stakeholders in the food and agriculture sectors with the goal of accelerating the nationwide adoption of innovative AgriFood technologies. The partnerships underscore Topian’s commitment to ensuring food security, enhancing local fish production, and reducing the carbon footprint caused by fish imports. Aligning with the United Nations Sustainable Development Goals, with a focus on the Life Below Water and Climate Action goals, Topian continues to transform the food system and contribute to the Kingdom’s socio-economic and environmental objectives.

Norway currently has a rich fish farming sector, holding the title of not only the largest salmon producer but also the largest exporting country of seafood in the world. In 2021, more than 837 million salmon were farmed in Norway and in 2021 the country produced almost 54 percent of Atlantic salmon in the whole world. The first major breakthrough for the industry came through in the 1970s when the first sea cage was constructed. The coast of Norway proved to provide excellent conditions for farming since it had not only good shelter for the cages, but also a reliable water temperature thanks to the Gulf stream.
One of the reasons why fish farming in Norway became so popular was because of how many generations of fish you can farm compared to regular cattle and due to the high number of offspring each fish produces. The average generation interval in salmon is two years, 60 percent faster than that of beef cattle, and on average each female atlantic salmon lays between 200010,000 compared to cattle where they usually only birth one offspring. This fast generation turnaround along with the large sizes of each generation is one of the things that allowed Norway to grow their fish farming sector, especially since the safety of the hatcheries where the eggs are hatched allowed many more eggs to survive than in the wild where a majority of the eggs laid by the female salmon will be eaten by predators. Another reason for the growth of the industry in Norway is because of the high price of salmon as a product. Salmon was not available everywhere in the world and the fact that the farmers in Norway were able to farm salmon for a low cost compared to its market value meant that those who started farming from the beginning were making very good money, this drew more people into the business and caused the industry to grow rapidly.
In recent years most salmon farms consist of six to ten sea cages, each of which can hold up to 200,000 salmon.
The bottlenecks
This farming method is not perfect, however. The primary method is farming fish in open net pens along the coast and in Fjords, but escapes are common with this method, which allows the farmed fish to spread diseases into the wild population and interbreed with wild salmon rather than the other farmed fish that can then be used for further breeding or as food. Some experts say that the interbreeding of wild fish with farmed fish can also cause future generations of the salmon to have a shorter lifespan, which can potentially endanger the species in areas if there is an escape of a large enough level.
Last September, the Norwegian government set out a proposal to raise taxes on the industry. Aimed at sharing the profits of one the country’s key resources, the idea was widely described as a ‘salmon tax’ and set at 25 percent. Within hours, share prices for salmon firms plummeted, hare prices for Norway’s major salmon companies, including Mowi, SalMar and Grieg Seafood, took a hit. Experts say such taxes on ocean resources, as well as supporting local communities, have the potential to limit destruction of the marine environment by making ocean-based activities that damage it. Albeit the Salmon tax doesn’t guarantee better environmental regulations, it could lead to an improved income distribution, says the government.
There are companies within Norway which are already coming up with new ideas to try and combat these issues, such as

SalMar, who have recently constructed the world’s largest offshore fish farm off the coast of Norway. This method proves to be better for the health of the fish with the currents of the ocean reducing the concentration of parasites, meaning that they cannot stay on the fish and therefore cause less/no harm to them. Along with this, the fact that the farm is further away from the shore means that there is a much lower chance that the farmed fish will interact with wild fish, which decreases both interbreeding and disease spreading amongst both parties.
Bluegreen, another company in Norway, has recently launched a very interesting piece of technology that could prove to be extremely influential and helpful to the future of the fish farming industry as a whole. This has been done with the invention of the Marine Donut. The Marine Donut is a closed containment system for fish farming that also leaves a minimal environmental footprint and gives the user good control over the efficient feed factor, which can reduce their running costs. One Marine Donut can hold 1100 tonnes of biomass and can be used across all different stages of the fish’s growth. While early signs point to this technology being useful for farmers and something that could help combat the negative aspects of fish farming on the ocean population, it is important to keep in mind that this technology is still in its infancy and extremely new, especially compared to the farming cages that have been used for decades.
The aquaculture industry has come a long way in Norway, from its primitive start in the 1960s and 70s to becoming the largest producer of farmed salmon, in 2022 they had a production of over 1.4 million tonnes. One of the special aspects of Norway’s aquaculture industry is how export orientated it is, with over 95 percent of the country’s seafood production being exported to over 100 countries. The constant push for companies to continue advancements is something that helps Norway stay so high in the aquaculture industry. Every two years all of the leading companies gather at Aqua Nor in Norway to showcase their latest products and services and with time these have become increasingly advanced, showing both the technological improvement and the competitiveness of the Norwegian industry.
It seems like the future of aquaculture is in safe hands with Norway, aquaculture is an important part of the country and vice-versa and they have many companies working hard to bring the industry into the 21st century in terms of sustainability, conservation and technology. While it is important to protect the ocean as well as its inhabitants we must do everything we can to make sure that the industry is not left behind, but instead make sure that it advances with time so that it can continue to be successful and that future generations can enjoy it and all its benefits, especially when we consider all of the hard work that

Legal business advice:
• Mariculture and Aquaculture leases
• Aquaculture and mariculture disputes
• Commercial fishery issues
• Acquisition and ownership of fisheries
• Registration of fishing rights
• Defence of fisheries prosecutions
• Seizure of fishing vessels
• International fishing licenses
• High seas fishing

Ozone is a powerful reducing agent that effectively targets organic matter, viruses, bacteria and parasites. Since the beginning of the last century, ozone has been used to purify municipal wastewater. Following, it has been introduced as water treatment in aquariums, swimming pools, drinking water, industrial process water and also water used in fish farming.
Recirculation Aquaculture Systems (RAS) are land-based systems where fish are farmed in reused water. The water in these intensive production systems is heavily loaded by organic matter which allows microorganisms to proliferate. Some of these microorganisms produce small molecules such as geosmin and 2-methylisoborneol (MIB), which may introduce an undesirable muddy or musty flavour in the fish.
Even extremely small amounts of these off-flavor compounds
(OFCs) lead to a muddy taste in the fish, making it unmarketable and unsuitable for human consumption. The common practice to deal with OFCs is purging the fish in clean water, while depriving them of food which results in a significant amount of weight loss (>5%) while a very large amount of clean water is needed. This is time-consuming and takes up to 15 days, but also waterconsuming and costly, costing up to five percent of the revenue.
Ozone targets OFCs and may introduce a new way to avoid the purging of fish grown in RAS.
The geosmin challenge is one of the biggest challenges for landbased fish farming and solving this would be a game changer for RAS. One effective way of eliminating the OFCs is to treat the water with ozone.
However, ozonated water in large-scale RAS and flow-through fish farms have had different challenges.
Historically ozone generators have been big and complicated and were placed far from the treatment site and lead to the fish tanks through long pipes. But ozone rapidly decomposes and turns to pure oxygen, losing its oxidative properties. This is beneficial for the water environment and biofilter, but when most of the ozone has been degraded to oxygen before even reaching its goal, it made the treatment ineffective and expensive in RAS.
This problem has been solved with the ozone generator Gaia, developed by Water ApS. Gaia is one of the most powerful and high-producing generators on the market. Gaia is a modular ozone generator separated into smaller units working separately. The modular prospects of the generator make it possible to place the generator directly at the treatment site and treat the water without any loss of ozone. This makes the ozonation process

highly effective, and much cheaper in use.
Gaia works along with the OxyGuard equipment; the Pacific, a measuring, monitoring and control system and the Ozone Sensor, developed to detect even the smallest amount of residual ozone. Supervision and control of ozone are necessary. Ozone is toxic to the fish, if not fully consumed when it reaches the fish tanks.
But there are several solutions to make it safe. UV radiation in conjunction with ozone will destroy the residual ozone. With Helios UV technology (from Water ApS) you can make the UV radiation a part of your set-up. Supervision and control
are manageable from anywhere online with the digital farm management tool Cobália.
Paw Petersen, CEO at OxyGuard International thinks that ozone is an essential player – moving forward; “In our ever-evolving aquaculture industry, we need to sharpen our focus on the water quality in RAS. Here, an essential player emerges: ozone.
Despite its three-decade presence in RAS, ozone has now become more accessible. Today we can measure and control the ozonation process in the same way we have done with oxygen in the past 40 years.


This will revolutionize farm building designs, improve water quality standards, lower the water usage in individual RAS setups and ultimately it will help land-based fish farming to hit the target”.
Ozone chemistry in saltwater is more complex compared to that in freshwater, due to the higher concentrations of dissolved ions.
Katerina Spiliotopoulou, Environmental Engineer at Water ApS explains: “Seawater naturally contains bromide ions (Br-) which are highly reactive to ozone. When ozonating seawater, bromide ion (Br−) is oxidized to hypobromite (OBr-), bromite (BrO2-) and eventually bromate (BrO3-) which are of crucial importance since they have long lifetimes allowing for several side reactions to occur. OBr- also reacts with ammonia and proteins to form bromamines. Both bromamines and hypobromous acid (HOBr) are toxic to fish, bivalves and crustaceans”. To ozonate safely salt water it is important to ensure the presence of organic matter. As long there is organic matter in the water ozone will react with it first as it is much easier to degrade than anything else.
OxyGuard solved this challenge with the fast-reacting ozone sensor that can measure ozone directly in the water in realtime. By adding the ozone sensor to the system, it is possible to ozonate safely based on feedback from the sensor.
On top of this solution, OxyGuard developed a control feature for ozonation in the Pacific Control System, enabling automated control of the ozonation based on feedback from the sensor.
The system has been tested through different developmental projects such as RASALT, where OxyGuard, in collaboration with DTU, the Technical University of Denmark, worked with
feedba ck from the ozone sensor and the ozone generator to avoid brominated by-product formation. The sensor and the generator were hooked up to the digital farm software, Cobália, and Cobália is now developing a module specifically for safe and efficient ozonation control. The aim is to automatically turn on and off the ozonation based on feedback from the water matrix. This add-on will increase security and efficiency, making it easy and cheap to use.
In ProBiOzon, another collaborative project between OxyGuard, DTU Aqua and primary producers, the effect of ozonation was tested on fish health and mortality in freshwater RAS. The results showed a general, overall improvement in fish health and following a lower mortality. It improves water quality by removing organic matter and it helps the biofilter function through the supply of pure oxygen for ozone degradation.
In a new project, Bizon, led by OxyGuard, the entire system will be tested full scale to see if ozonation could completely remove the need for purging or if it will only solve part of the challenge. The Bizon project concludes in 2026.
OxyGuard International and Water ApS have already implemented the system on several large RAS. It is installed as a part of the entire water cleaning setup on the farms, targeting a sub-stream of the recirculation water.
If the entire setup is effective enough to completely remove geosmin from the water, it will change the way we produce fish in RAS and the feasibility of RAS in general.
Underwater Contracting (UCO), a leading provider of underwater services to the offshore energy, inspection, construction, and aquaculture markets has developed a unique ROVdeployed system to repair small holes in fish farm nets.
The UCO NetFix repair system places plastic patches over holes in cage netting. Held firmly in position by pegs, the patches remain in place until the hole is permanently repaired by a dive team or when the nets are lifted to the surface.
Small holes, which can be made by predators or if equipment becomes snagged during operations, are identified during routine containment checks by ROV or during net washing. Until now, these would require calling out a dive team at short notice to carry out repairs, a time consuming and expensive process. NetFix uses the onsite ROV to carry out an immediate repair, ensuring containment of all stock.
Innovasea, a global leader in technologically advanced aquatic solutions for aquaculture and fish tracking, announced that its new NexTrak R1 acoustic telemetry receiver is now available for pre-order.
The R1 has shined in early field testing, giving aquatic animal researchers 40 percent greater range and double the detections compared to the previous technology.

“NexTrak was designed to provide researchers with deeper data sets so they could tackle new types of questions about animal behavior,” said Mark Jollymore, president of Innovasea. “We’ve been really pleased with how well the R1 receiver has performed in early deployments.”
NexTrak makes aquatic animal tracking easier by making deployments, maintenance and data retrieval more efficient. In addition, the range improvement and better coverage mean less equipment to purchase up front, lowering the total cost of ownership and making acoustic telemetry more accessible.
The NexTrak R1 is the first product in a larger NexTrak ecosystem that includes new receivers, transmitters and enhanced cloud-based tools that will provide researchers with a richer, more complete picture of animal behavior.

NLB Corporation introduced its latest innovation – the AQ3250 aquaculture unit. These cutting-edge pumps are engineered to thrive in the demanding environment of fish farm net cleaning, where salt spray and corrosion present continuous challenges.
NLB’s AQ3250 unit redefines industry standards with its unmatched corrosion resistance. Unlike traditional pumps, this unit employs ceramic plungers, which eliminate corrosion by the nature of their pre-oxidized chemical bonds. This breakthrough design ensures prolonged durability and operational reliability, even in the harshest conditions.
The AQ3250 plungers feature a remarkable six-micron finish, maintaining exceptionally smooth surfaces that significantly reduce wear. This advancement extends the life of crucial components such as packing, reducing the need for frequent replacements, and minimizing downtime.








The study identified that ASC certification offers tangible economic benefits, including increased prices and improved profitability, as well as fostering positive environmental practices and enhancing working conditions.
The study, completed in November 2023, focused on intensive farming of whiteleg shrimp. Thirty shrimp farmers and community members were interviewed in July and August 2023 at individual farm sites within the communities of Hoa Dong, Hoa Tu 2 and Vinh Phuo.
What are the main benefits of the ASC certification?
The case study identified that ASC certification can deliver many advantages for Vietnamese shrimp farms and their workforce. The scheme may offer tangible economic benefits, including increased prices and improved profitability, as well as fostering positive environmental practices and enhancing working conditions.
Community-level impacts are less clear and difficult to quantify without long-term and repeated data collection activities to assess whether impacts are being realised and/ or felt outside of the farm. However, ASC certified farms were found to have demonstrable benefits and positive perceptions
A recent study, carried out on behalf of Aquaculture Stewardship Council (ASC) by independent research firm MacAlister Elliott and Partners Ltd (MEP), has identified that ASC certification can deliver socio-economic and environmental benefits for Vietnamese shrimp farms and their workforce.
of certification in the communities though these farms also tend to have larger operations.
The study identified that although certified farms faced higher costs in electricity, production, and feed, farmers were able to secure better prices per tonne at the farmgate level (up to 76.4 percent higher), resulting in a more robust net income. This demonstrates the ASC scheme’s potential to enhance the profitability of farms and offset increased operational costs.
Interviews also revealed that ASC certified farms had to meet more stringent requirements in relation to antibiotic usage and wastewater treatment, and this could result in higher quality product that could attain a higher selling price for their shrimp.
Certified farms, which tend to be larger operations, were also found to have better scalability and greater environmental responsibility due to the strict operational requirements of ASC standards.
In terms of sales, ASC carried farms were found to sell directly to processing companies, enabling them to expand

their markets globally (Europe, America, Middle East). Farmers interviewed believe that the direct relationship between ASC certified farms and the buyer improves profitability.
Requirements for monitoring environmental impact and adopting management practices embedded in the ASC Shrimp Standard, such as for water quality, provided for stronger environmental stewardship on ASC certified farms. However, it is not clear whether the surrounding community can also benefit from this. The VietGap programme, in contrast to ASC, is tailored specifically to the Vietnamese shrimp industry and therefore is more widely recognised and likely provides environmental benefits at scale.
Surveys found a perceived improvement in working conditions at ASC certified farms, suggesting a direct benefit to workers because of certification. ASC certification comes with a cost to implement many of the requirements – such as those related to the working environment – and it has been shown that employees benefit from these changes, such as employment opportunities, farmer networks and enhanced worker health and safety.
ASC commissioned the study and from 13 proposals with varying approaches and scopes, they selected MacAlister, Elliott and Partners (MEP).
The case study looked at the potential socio-economic and environmental benefits realised by ASC certified shrimp producers in Vietnam. The study categorised three clusters of farming operations to represent ASC certified farms, non-certified farms and farms certified under the VietGap (Vietnamese Good Agricultural Practices) programme; this third group represents partial certification. MEP reviewed ASC data, and field staff conducted interviews and focus group discussions with representative shrimp farmers and communities to collect data on farm performance and assess benefits and perceptions of certification.
The study took about nine months to complete, and given the small scope, ASC acknowledge this as a case study that has helped them identify strengths, weaknesses and methodological opportunities to apply to future studies.





2024 March
3-7
World Fisheries Congress 2024
Washington, USA
https://wfc2024.fisheries.org
5-7
19th North Atlantic Seafood Forum Bergen, Norway
https://nor-seafood.com
10-12
Seafood Expo North America Boston, USA
www.seafoodexpo.com
11 Aquatic Conference
Bangkok, Thailand
www.aquafeed.co.uk/companies/aquatic
The Aquatic conference, held at VICTAM Health and Nutrition Asia 2024, will be on March 11, 2024. With the theme being ‘Future World Feed Through Aquaculture’, the conference will focus on the future of aquaculture and feed within the industry. Co-organised between Perendale Publishers Ltd and VIV Worldwide, Aquatic will be held at BITEC, room MR 224 at 10:00am. If you are interested in sponsoring Aquatic and would like a chance to speak then please get in touch with either Severina Proskurnova at severina@vnueurope.com or Tuti Tan at tutit@perendale. co.uk. If you would like to attend the conference then please register your attendance through this link: http:// myaqua.info/cPIZ.
11
Petfood & Aquafeed Extrusion Conference
Bangkok, Thailand
www.aquafeed.co.uk/companies/ petfood-aquafeed-extrusionconference/
Petfood & Aquafeed Extrusion Conference (PAEC), held at VICTAM Health and Nutrition Asia 2024, will be on March 11, 2024. With a focus on the extrusion of feeds and the related equipment used, the one-day conference will feature a variety of speakers covering all the key-areas of the industry to give the latest extrusion information. Co-organised between Perendale Publishers Ltd and VIV Worldwide, PAEC will be held at BITEC, room 223 at 10:00am. To be a sponsor and speaker email Dr Mian Riaz at mnriaz@ tamu.edu. More information can be found at https:// millingandgrain.com/companies/petfood-aquafeedextrusion-conference/.
12-14
Health and Nutrition Asia 2024
Bangkok, Thailand https://vivhealthandnutrition.nl
12-14
VICTAM Asia 2024
Bangkok, Thailand https://victamasia.com
13
Build My Feedmill
Bangkok, Thailand www.aquafeed.co.uk/companies/ build-my-feedmill/

14
Flour Milling Maximised Bangkok, Thailand www.aquafeed.co.uk/companies/ flour-milling-maximised/ 17-21
116th Annual Meeting of the National Shellfisheries Association North Carolina, USA www.shellfish.org/annual-meeting 19-21
AQUASUR 2024
Puerto Montt, Chile www.aqua-sur.cl/en/
20-23, VietShrimp
Ca Mau City, Vietnam https://vietshrimp.net/
2024 April
6-7
AquaH
Birmingham, United Kingdom https://aquah.co.uk
AQUAH was born from the need for a much-deserved event for the ever-expanding and passionate UK aquatics and reptile community. Enthusiasts will have access to a diverse range of exotic reptiles, amphibians and invertebrates, along with freshwater plants and fish, Japanese Koi, marine fish and quality imported and aqua cultured corals 'home grown' by vendors across the country. With the rare opportunity to socialise with like-minded hobbyists, this is truly an event you do not want to miss!
23-25
The Global Seafood Marketplace Barcelona, Spain www.seafoodexpo.com
2024 May
8-11
International Indonesia Seafood & Meat Expo
Jakarta, Indonesia https://iism-expo.com/
8-11
Indonesia Cold Chain Expo Jakarta, Indonesia https://iism-expo.com
14-15
Aquaculture UK Aviemore, Scotland https://aquacultureuk.com
15-17
Seafood Expo
Eurasia - May, İstanbul, Türkiye https://seafoodexpoeurasia.com
21-22
Blue Food Innovation Summit London, England
www.bluefoodinnovation.com
27-31
International Symposium on Fish Nutrition and Feeding (ISFNF) Puerto Vallarta, Mexico www.isfnf2024.com
2024 June
18-20
Seagriculture EU 2024
Torshavn, Faroe Island https://seagriculture.eu

19-21
Aquaculture Taiwan 2024
Taipei, Taiwan
www.aquaculturetaiwan.com
24-26
4th Edition of World Aquaculture and Fisheries Conference Paris, France
www.worldaquacultureconference.com
2024 July
2-5
Asia-Pacific Aquaculture 2024 Surabaya, Indonesia
www.was.org/meeting/code/APA2024
17-19
IndoFisheries 2024 Expo & Forum
Jakarta, Indonesia https://indofisheries.id












The international exhibition-conference event, Aquafarm 2024, dedicated to aquaculture and sustainable fishing industry organised in collaboration with API, the Italian Fish Farmers Association and AMA, the Mediterranean Aquaculturists Association has been held from 14-15 February 2024 at Pordenone, Italy. As always, the exhibitions showcased latest innovation with in the industry and visitors from all over the world turned up to witness the latest industry trends.
International Aquafeed was fortunate to be of attendance. We had the pleasure to meet with numerous companies including Faivre, Vetagro, Aller Aqua, Necton, Pt Aqua etc. Our Content Development Manager, Costa Skotidas, had the opportunity to chair one of the sessions and we proud to have contributed to this industry shaping event.
Today the aquaculture sector is universally recognised as a rapidly growing essential sector. However, its importance is accompanied by inherent challenges due to the number of influencing factors: technical, biological, environmental, economic and even social. Recognising the need for continuous innovation, particularly in production processes, the session dedicated to technological innovation in farming talked about new technologies capable of optimizing the entire supply chain. Another session also talked about how artificial intelligence and data







analysis play a fundamental role in improving efficiency and decision-making in the aquaculture sector.
We met Nuno Medina from Aquasoja who shared his insights on the show with us, “Italy is a very interesting market, it has always been. Italy has an importance in the area – it is close to markets like Croatia, Slovenia, North of Africa.”
“So when we participate this event, it is to address this kind of market. And to communicate the solutions that we have. “
At AquaFarm researchers and innovators presented projects that have the important aim of making the sector more sustainable through the optimisation and improvement of primary resources and ingredients.
Research has always been the best ally for looking to the future. In the conference dedicated to technologies and trends in research, researchers and experts from all over the world presented the latest news relating to animal welfare throughout the entire breeding cycle, the use of fish skin in medical therapies, new methods for selection and much more.
We got to meet many companies who shared their Aquafarm experience with us.
CEO of Ittinsect shared, “We are exhibiting today our protein meal, which we call ‘beyond fish meal’. It is a protein that replicates the nutritional profile








 Pierluigi Erroi, Allesandro Romano, Alessia Ramondo, Andrea D”Addazio, Riccardo Gilioli – Ittinsect
(L-R) David Maerkl-Bilger, Alexander Rose – Water Proved GmbH
Pierluigi Erroi, Allesandro Romano, Alessia Ramondo, Andrea D”Addazio, Riccardo Gilioli – Ittinsect
(L-R) David Maerkl-Bilger, Alexander Rose – Water Proved GmbH
of fishmeal. We’re trying to meet fish farmers from Italy. And so, it’s really an event where we can socialise to increase our business. We have already met quite a few clients. The reason why we’re here is mainly to improve quantities of feed sold to each client.”
Head of Development at More Fish commented, “This is the first time we are attending Aquafarm. And the European aquaculture is very interesting for us. The fish farms maybe not technological advanced compared to Norway. But I think we can help increase the productivity and also spread some knowledge. This fair is a very nice place to be as there is a lot companies that are new to us and we have met some very nice people.”
Media Manager for Necton said, “This is an amazing place to not only nurture relationships that you already have with the industry, but it’s also a good place to form new relationships. And it’s a great way to feel the pulse of the market, especially for the younger folks or industry in the Italian market. We have some true power, our aquaculture powerhouses is always present here, so it’s a great place to visit.”
Fabrizio Caruso from Vetagro detailed, “we are here and the main goal is to make ourselves known as much as possible, to as much people as we as we can and to show them what we can do. And we are very happy to see that Aquafarm looks amazing as every year.”
AquaFarm is an international exhibition-conference on aquaculture and the sustainable fishing industry, organized by Pordenone Fiere in collaboration with API, the Italian Fish Farmers Association. AMA, Mediterranean Aquaculture Association, and with Studio Comelli –Conferences&Communication, which looks after the contents of the conferences and the press office.








 (L-R) Soraya Koulitchenko, Agostino Basile – Ecoline France
Aubert Faivre, Faivre and Joel Bartolic, Mutlifoodpak
(L-R) Fabrizio Caruso, Giacomo Petroni – Vetagro
Andea Fanelli, Dr Salvatore Falciglia
(L-R) Costa, Bjorn Ronge, Svein Marinsen – MoreFish
Costa, Joäo Pedro Pires –PhytoBllom – Microalgae by Necton
(L-R) Ivana Lepen Pleic, Tanya Segvic Bubic, Tania Borisa Pecigos, Leon Grubisic - Institute of Oceanography and Fisheries split
(L-R) Soraya Koulitchenko, Agostino Basile – Ecoline France
Aubert Faivre, Faivre and Joel Bartolic, Mutlifoodpak
(L-R) Fabrizio Caruso, Giacomo Petroni – Vetagro
Andea Fanelli, Dr Salvatore Falciglia
(L-R) Costa, Bjorn Ronge, Svein Marinsen – MoreFish
Costa, Joäo Pedro Pires –PhytoBllom – Microalgae by Necton
(L-R) Ivana Lepen Pleic, Tanya Segvic Bubic, Tania Borisa Pecigos, Leon Grubisic - Institute of Oceanography and Fisheries split






Victam Asia and Health & Nutrition Asia 2024 will take place from March 12 - 14, 2024 at BITEC Exhibition Center in Bangkok, Thailand.
Victam Asia is the premier event for the sophisticated technology that is required in the processing and manufacture for the animal feed industry. The show also covers the important and very necessary ancillary equipment and systems that are utilized in a feed mill. Victam is also the event for ingredients and additives that are used within the formulation of safe and cost effective animal feeds.
Victam Asia 2024 and Health & Nutrition consists of 2 main profiles: animal feed technology and animal health and nutrition. Co-located is Grapas Asia, the event dedicated to the grain and rice processing industries within Asia. Each of the shows is complimented by a number of conferences on various current topics within the mentioned industries.
VIV Health & Nutrition Asia addresses fast-moving sectors such as feed ingredients & additives, pharmaceutics and pharmaceutical ingredients, genetics and more.
The Grapas event also displays ancillary equipment that is found within a mill, but its main coverage is for specialist systems and technology used within rice & flour mills, together with additional exhibits for grain storage, preservation and transportation. The show also profiles noodle, breakfast cereals and extruded snack production.


aquafeed.co.uk/web/companies
Welcome to the market place, where you will find suppliers of products and services to the industry - with help from our friends at The International Aquafeed Directory (published by Turret Group).
Aerators
Faivre
+ 33 3 81 84 01 32 www.faivre.fr
PROFILE: myaqua.info/JEzZ
Air products
Kaeser Kompressoren
+49 9561 6400 www.kaeser.com
PROFILE: myaqua.info/okuN
Additives
DSM
+43 2782 8030 www.dsm.com
PROFILE: myaqua.info/uJDB
Jefo
+1 450 799 2000
https://jefo.ca
PROFILE: myaqua.info/mQBf
Liptosa
+34 902 157711 www.liptosa.com
PROFILE: myaqua.info/iZqf
SAS Laboratories Phode
+33 5 63 77 80 60 www.phode.com
PROFILE: myaqua.info/XtAr
Romer Labs
+43 2272 6153310
www.romerlabs.com
PROFILE: aqfeed.info/e/1610
TSC Silos
+31 543 473979
www.tsc-silos.com
PROFILE: myaqua.info/YZlV
Cablevey Conveyors
+1 641 673 8451
https://cablevey.com
PROFILE: myaqua.info/EKbO
Vigan Enginnering
+32 67 89 50 41 www.vigan.com
myaqua.info/aXKo
Inteqnion
+31 543 49 44 66 www.inteqnion.com
PROFILE: myaqua.info/mSNu
Bühler AG
+41 71 955 11 11
www.buhlergroup.com
PROFILE: myaqua.info/qREy
FAMSUN
+86 514 85828888
www.famsungroup.com
PROFILE: myaqua.info/Esjj
IDAH
+866 39 902701
www.idah.com
PROFILE: myaqua.info/eCVS
Wenger Manufacturing
+1 785-284-2133
www.wenger.com
PROFILE: myaqua.info/plVJ
Faivre
+ 33 3 81 84 01 32
www.faivre.fr
PROFILE: myaqua.info/JEzZ
Faivre is a French company, and one of the world leaders in the conception, manufacture and production of aquaculture machines.
Since 1958, thanks to their knowledge of the market and strong experience in aquaculture, Faivre has developed high quality products to satisfy all of your needs, from one product to the full installation. Strength, effectiveness and simplicity are the qualities of their production.
myaqua.info/JEzZ

Tapco Inc
+1 314 739 9191
www.tapcoinc.com
PROFILE: myaqua.info/rCyw

Elevator & conveyor components
Enzymes
4B Braime +44 113 246 1800 www.go4b.com myaqua.info/vPJh
DSM
+43 2782 8030 www.dsm.com
PROFILE: myaqua.info/uJDB
Equipment for sale
Extruders
Feed Mill
ExtruTech Inc
+1 785 284 2153 www.extru-techinc.com
PROFILE: myaqua.info/DhbW
Almex
+31 575 572666 www.almex.nl
PROFILE: myaqua.info/zjHK
Buhler AG
+41 71 955 11 11 www.buhlergroup.com
PROFILE: myaqua.info/qREy
IDAH +866 39 902701 www.idah.com
PROFILE: myaqua.info/eCVS
Ottevanger
+31 79 593 22 21 www.ottevanger.com
PROFILE: myaqua.info/prYd
Wenger Manufacturing
Fish counters
Liptosa
+34 902 15 77 11
www.liptoaqua.com
PROFILE: myaqua.info/iZqf
Phileo (Lesaffre animal care)
+33 3 20 81 61 00
www.lesaffre.fr
PROFILE: myaqua.info/vqCK
TekPro
+44 1692 403403
www.tekpro.com
PROFILE: myaqua.info/QcZG
Tietjen Verfahrenstechnik GmbH
+49 4106 6333 0
www.tietjen-original.com
PROFILE: myaqua.info/wiyw
Van Aarsen International
+31 475 579 444
www.aarsen.com
PROFILE: myaqua.info/sBGT
Faivre
+ 33 3 81 84 01 32
www.faivre.fr
PROFILE: myaqua.info/JEzZ
+1 785-284-2133 www.wenger.com
PROFILE: myaqua.info/plVJ
Zheng Chang +86 2164184200 www.zhengchang.com
PROFILE: myaqua.info/zQxZ
Adisseo
+33 1 46 747104 www.adisseo.com
PROFILE: myaqua.info/iGee
Aller Aqua
+45 70 22 19 10 www.aller-aqua.com
PROFILE: myaqua.info/AnqC
Alltech
+44 1780 764512 www.alltechcoppens.com
PROFILE: myaqua.info/mTpk
Anpario
+44 1909 537 380 www.anpario.com
PROFILE: myaqua.info/uyJL
Biorigin
www.biorigin.net
PROFILE: myaqua.info/SGjW
GePro
+49 54415 925252 www.ge-pro.de myaqua.info/UzqV
Grand Fish Feed
+202 20 650018
www.grand-aqua.com
PROFILE: myaqua.info/mqSu
Jefo
+1 450 799 2000
https://jefo.ca
PROFILE: myaqua.info/mQBf
Symrise
https://aquafeed.symrise.com
PROFILE: myaqua.info/fEOD
Pellet mill
IDAH
+866 39 902701
www.idah.com
PROFILE: myaqua.info/eCVS
PTN
+31 73 54 984 72
www.ptn.nl
PROFILE: myaqua.info/Zapi
Buhler AG
+41 71 955 11 11
www.buhlergroup.com
PROFILE: myaqua.info/qREy
Dinnissen BV
+31 77 467 3555
www.dinnissen.nl
PROFILE: myaqua.info/loTI
FAMSUN
+86 514 87848880
www.muyang.com
PROFILE: myaqua.info/Esjj
Ottevanger
+31 79 593 22 21
Fish Graders
Faivre
+ 33 3 81 84 01 32
www.faivre.fr
PROFILE:myaqua.info/JEzZ
Fish pumps
Faivre
+ 33 3 81 84 01 32
www.faivre.fr
PROFILE: myaqua.info/JEzZ
Grinders
Hammermills
Grand Fish Feed
+202 20 650018
www.grand-aqua.com
PROFILE: myaqua.info/mqSu
Dinnissen BV
+31 77 467 3555
www.dinnissen.nl
PROFILE: myaqua.info/loTI
Tietjen Verfahrenstechnik GmbH +49 4106 6333 0 www.tietjen-original.com
PROFILE: myaqua.info/wiyw
Moisture analysers
Packaging
Hydronix +44 1483 468900 www.hydronix.com
PROFILE: myaqua.info/FkMu
www.ottevanger.com
PROFILE: myaqua.info/prYd
Zheng Chang
+86 2164184200
www.zhengchang.com
PROFILE: myaqua.info/zQxZ
IDAH
+866 39 902701
www.idah.com
PROFILE: myaqua.info/eCVS

FAWEMA / The Packaging Group +49 22 63 716 0 www.fawema.com
PROFILE: myaqua.info/oeDC
Paddle Mixer
IDAH
+866 39 902701 www.idah.com
PROFILE: myaqua.info/eCVS
Palatability enhancers








DSM-Firmenich
+43 2782 8030
www.dsm.com
PROFILE: myaqua.info/uJDB
Royal DSM is a global, purpose-led company in Health, Nutrition & Bioscience, applying science to improve the health of people, animals and the planet. DSM’s purpose is to create brighter lives for all. DSM’s products and solutions address some of the world’s biggest challenges while simultaneously creating economic, environmental and societal value for all its stakeholders - customers, employees, shareholders, and society at large. DSM and its associated companies employ approximately 23,000 people around the world and deliver annual net sales of about €10 billion.
DSM use their bright science to deliver positive transformations at scale for as many people as possible today and for generations to come, operating within the constraints of the world’s finite resources. DSM aim to redefine how they live and work in order to create a fairer, more prosperous and more sustainable society.
In Animal Nutrition and Health
The DSM Animal Nutrition and Health business group offers customers a true end-to-end portfolio of products, solutions and services for sustainable and profitable animal farming. The company’s three dedicated business lines cover Precision Services, Performance Solutions + Biomin® and Essential Products.
Precision Services
Greater precision in animal farming is key to a more sustainable and profitable future. Their Precision Services use the latest data analytics and diagnostics to improve animal health, lifetime performance, resource use and environmental footprint — while mitigating risks and unlocking more value. Improving the sustainability and profitability of animal farming is secured with, aqfeed.info/e/1605
Fish Farm Feeder
+34 886 317 600
www.fishfarmfeeder.com
PROFILE: myaqua.info/PKBM
FishFarmFeeder is a company founded in 2008 that manufactures feeding systems for aquaculture with a complete catalog of feeders that cover all stages of the fish's life: hatchery, pre-grower and grow-out, both on land and at sea.
FishFarmFeeder’s mission is to:
• Offer globally specialized solutions only in the field of feed automation for aquaculture.
• Contribute to a sustainable aquaculture helping to optimize production and improving fish welfare.
Respond to the needs of automation in the feeding of all stages of the fish's life.
• Develope a profitable, reliable, accurate and safe technology.
• Facilitate integration with other existing technologies in aquaculture such as sensors, software aqfeed.info/e/1603
TSC Silos
+31 543 473979
www.tsc-silos.com
PROFILE: myaqua.info/YZlV
Dinnissen BV
+31 77 467 3555
www.dinnissen.nl
PROFILE: myaqua.info/loTI
Ottevanger
+31 79 593 22 21
www.ottevanger.com
PROFILE: myaqua.info/prYd
Leiber GmbH
+49 5461 93030
www.leibergmbh.de
PROFILE: myaqua.info/e/gTlw
Phileo (Lesaffre animal care)
+33 3 20 81 61 00
www.lesaffre.fr
PROFILE: myaqua.info/vqCK



Aqua Ultraviolet
+1 952 296 3480
www.aquauv.com
PROFILE: myaqua.info/KbEj

FAMSUN
+86 514 85828888
www.famsungroup.com
PROFILE: myaqua.info/Esjj
Rizky Darmawan is the CEO of Delta Marine Group, a pioneering aquaculture company specializing in sustainable shrimp production, distribution, and processing. With a Bachelor of Science degree in Aquatic and Fisheries Sciences from the University of Washington, Seattle, Rizky combines education with innovation to reshape the shrimp industry.
As the President of Petambak Muda Indonesia since its inception in 2015, Rizky Darmawan is dedicated to educating and fostering solidarity among young aquaculturists. His leadership shines through the annual “Shrimp Aquaculture Conference” in Bali, a cornerstone event for knowledge-sharing and collaboration in the field.
You have a rich career in the industry, what initially lead you to this field?
When I went to the US for my university education, I knew from the start that I wanted to return to Indonesia and build businesses. Since my family business is already in the shrimp farming industry, I decided to pursue a relevant degree to understand it. Then, after I finished my studies and returned, I saw many young farmers in the same boat as I was, plunging into this industry without much knowledge. So, a couple of people and I decided to create PMI (Petambak Muda Indonesia), a community for young farmers who want to learn more about shrimp farming and improve their farms. We successfully created a fun community built for solidarity and learning. From then on, I decided this was a good industry to settle in and grow.
As the CEO of Delta Marine, you’ve undoubtedly encountered various challenges in the aquafeed industry. Can you share a particularly significant obstacle you’ve faced and how your personal values and leadership philosophy guided you through it?
Yes, we encountered various challenges regarding aquafeed, especially with feed quality and use. When I started to be involved in the business, our production was inconsistent. We used multiple feed brands, and there was no real comparison method. So, we decided to focus on 2-3 feed brands and test them. We picked the feed mills we know have a good reputation and QC. From there, we can find who has the best performance. However, we also decided not to rely on just one feedmill/feed brand. We made a policy of using more than one feed brand so that we can always check on their quality over time and give feedback to the feed mill. We treat our feed supplier as our partner. We look for like-minded partners who want to grow together with us and support each other.
What are your personal beliefs regarding the importance of sustainability in aquaculture, and how do they align with the company’s goals and practices?
I believe sustainability is essential, not just in aquaculture but in all industries. However, I believe sustainability is not just tethered to the environmental side but also to its business and social aspects. It doesn’t matter how environmentally friendly your operation is; if you can’t make a profit, the business will not last. It is the same as the social impact you can give your surroundings. Environmental impact is important, but it is one part of the puzzle. In our operation, we keep striving to fulfill all of these goals. We keep innovating and trying new ways to be more efficient in using our resources. We try to reduce our carbon footprint. And we always try to give back to the community and give fair compensation to our team members.
In your opinion, what are the most pressing challenges or opportunities in the aquafeed industry today, and how do you believe Delta Marine can continue to make a positive impact in addressing them?
One of the pressing challenges in the aquafeed industry is the supply of raw materials. Due to the conflict in Europe and climate change happening worldwide, we see a reduction in volume and a price increase. This will be a challenge for the aquafeed industry, and I believe this is where we can see the difference between the good and the great feedmillers/nutritionists. This can also be an opportunity to showcase their knowledge and expertise in this industry.
On the side, this is also an opportunity for alternative feed ingredients producers such as algal meal, BSF meal, or single cell protein meal to start increasing their production and replace those scarce resources.
Looking ahead, what are the key trends and opportunities you foresee in the aquafeed industry, and how does Delta Marine plan to stay at the forefront of these developments?
We believe the key trends that will develop in the near future is that there will be a number of “niche” feeds coming up, feeds that pride themselves on using more sustainable and/or alternative ingredients. These feeds will also be promoted down the line to market a more sustainably produced products to the consumers. For Delta Marine, we are committed to trying and finding new ways to improve the sustainability of our operation, and one of the ways to achieve this is through the feed we use. We are open to testing these kinds of feeds to see their performance and economic viability. Down the line, we hope that this will also be a
Where do you think the industry will be by 2050?
I think in 2050, the shrimp business will be more consolidated, with several big companies being more prominent in the industry. The shrimp industry right now is in the middle of a crisis, where production costs keep increasing while shrimp selling price is at a low point. This will test the efficiency of existing farms and create a natural selection process. And as production goes up and the market becomes more competitive, I see more marketing being done in-house within each company to fight for market share. When this happens, we will see a lot of creative ways people try to differentiate their products.




Phibro Saúde Animal, a global animal health and nutrition company, announces the hiring of Eduardo Criscuolo Urbinati to manage the company’s aquaculture business in Brazil. The professional will be responsible for supporting the line of fish and shrimp products, technically training the commercial team and meeting demand generation and sales.
Urbinati has a degree in biological sciences from Centro Universitário de Araraquara, in 2009, and a master’s degree in aquaculture from Universidade Estadual Paulista (Unesp), a title obtained in 2012, after studying the relationship between prostaglandin F and ovulation in pacu breeders. With 15 years of experience, he has worked for large companies and held leadership roles.
“It is a great pleasure to arrive at Phibro to contribute to the growth of the company and Brazilian aquaculture, objectives that go hand in hand, considering that our products – such as PAQ-Gro and PAQ-Protex – are fundamental to a successful activity, with healthy animals, more productivity and profitability”, comments the new manager.
Urbinati will also work to expand the business of the PhiShield line of autogenous vaccines for aquaculture. Phibro’s country manager in Brazil, Mauricio Graziani, highlights the biologist’s competence: “The experience and competence that Eduardo Urbinati adds to our team will certainly be differentiators in meeting our goals and developing a strategy increasingly based on the needs of our clients, always following sustainable principles.”
E Michael Castle II has been appointed chief operations and financial officer at Alltech.
Castle has been with Alltech for 19 years, most recently serving as chief operating officer and CEO of the Alltech Feed Division. He has deep experience in the business globally, having also served as chief administrative and legal officer, among other roles.
Castle began his career at Alltech as an engineering intern. He went on to earn a Juris Doctor from Washington University St Louis School of Law and then returned to Alltech.
“Having worked with Alltech for almost two decades. Mike has Alltech DNA through and through. He worked closely with our leadership team and my father on many of the most important deals in our history. Since the passing of Dr Pearse Lyons in 2018, Mike and I have worked hand in globe to lead the business,” said Dr Mark Lyons, president and CEO of Alltech. “In all his endeavours, Mike has demonstrated unparalleled dedication, exemplary leadership and passion for excellence. He is an invaluable asset to Alltech, and a trusted friend and colleague to me. There is no one better prepared – and no one I’d rather work alongside – to lead Alltech into the future.”
MiAlgae, an Edinburgh-based company that grows algae using by-products from the local whisky industry to make a high-quality Omega-3 product, has announced the role as they build new revenue streams and promote business growth.
Chris joins MiAlgae from French company Agronutris, who specialise in the rearing and transforming of insects into sustainable proteins and fats for animal nutrition, where he held the role of Director of Business Development.
Chris has a long history in aquaculture having worked in various commercial roles in the Pan Fish Group from 1992 to 2005, including Sales and Marketing Director for Pan Fish Scotland, and then moved to a global marketing role with MSD Animal Health Aquaculture.
In 2017, he joined the animal nutrition sector, as Global Aquaculture Lead for Corbion Algae ingredients. Founder and Managing Director of MiAlgae, Douglas Martin commented: “We are extremely excited to welcome Chris to the team. He has the experience and talent we need to take MiAlgae to the next phase of its growth”.


Fish

